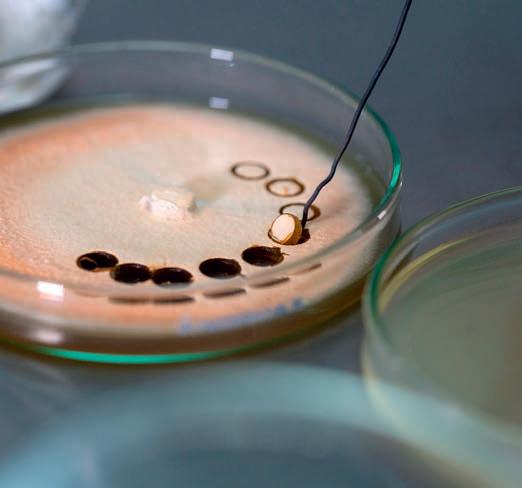
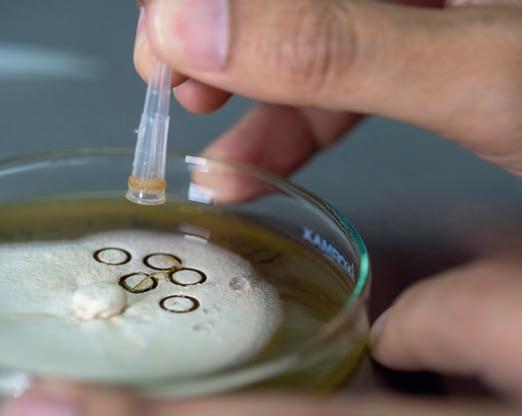

CIENCIA • TECNOLOGÍA • INNOVACIÓN
Vol. 57 nro. 178 | 2023
ISSN 0120-341X

CIENCIA • TECNOLOGÍA • INNOVACIÓN
Vol. 57 nro. 178 | 2023
ISSN 0120-341X

Tres promesas cumplidas con biotecnología criolla
El dulce sabor del cultivo de la paz
Inversión privada en justicia, posibilidad para mejorar acceso ciudadano
FOTO DE PORTADA
‘Serena’, la primera embarcación electrosolar de transporte rápido de pasajeros que se desarrolla en Latinoamérica.
Revista UNIVERSIDAD EAFIT
ISSN 0120-341X
Vol. 57 nro. 178 2023
@ Universidad EAFIT 2023
RECTORA

Claudia Restrepo Montoya
VICERRECTOR CIENCIA, TECNOLOGÍA E INNOVACIÓN
Antonio Julio Copete Villa
VICERRECTORA DE APRENDIZAJE
María Paola Podestá Correa
SECRETARIA GENERAL (E)
María Claudia Gómez Cabana
COMITÉ EDITORIAL
Antonio Julio Copete Villa
Natalia González Salazar
Daniel Hermelín Bravo
Nicolás Pinel Peláez
Catalina Suárez Restrepo
Ana María González Cotes
Agustin Patiño Orozco
Jhonathan Bustamante Cuartas
Óscar Caicedo Alarcón
Juan Fernando López
DIRECCIÓN
Vicerrectoría de Ciencia, Tecnología e Innovación
Laboratorio de Divulgación Científica EAFIT
COORDINACIÓN Y EDICIÓN
Juan Diego Restrepo E.
Óscar Caicedo Alarcón
Visítanos en el Portal de Revistas Académicas Universidad EAFIT publicaciones.eafit.edu.co
www.eafit.edu.co/investigacion
COMENTARIOS publicaciones@eafit.edu.co
Vigilada Mineducación
DISEÑO DIAGRAMACIÓN
Sara María Ochoa Botero
CORRECCIÓN DE ESTILO
Christian Alexander Martínez Guerrero
FOTOGRAFÍAS
Róbinson Henao Cañón
Cortesía y archivo
Las opiniones expresadas en este medio de comunicación son responsabilidad de sus autores y no corresponden a una posición institucional de la Universidad EAFIT
Propósito-misión
Inspirar vidas
Crear conocimiento
Transformar sociedad
Somos una comunidad de conocimientos y saberes aplicados para la solución de problemas, en conexión con las organizaciones, que genera valor y desarrollo sostenible
Campus principal Universidad EAFIT
Carrera 49 7 Sur-50
Teléfono: (57) (4) 2619500
Ext.9883
Medellín, Colombia
EAFIT Pereira
Carrera 19 12-70
Megacentro Pinares
Teléfono: (57) (6) 3214115
EAFIT Llanogrande
Kilómetro 3.5
Vía Don Diego-Rionegro
Teléfono: (57) (4) 2619500
Ext.9562-9188
EAFIT Bogotá
Carrera 21 87-85
Teléfono: (57) (1) 6114618
Editorial La ciencia en el corazón de
6
Crea ¡Contemplen el Museo de los Esfuerzos Inútiles!
Redes y alianzas El dulce sabor del cultivo de la paz
4 22 44
ConCiencia
El valor social de las organizaciones, bajo el análisis de Bien Plus
Proyectos CTeI Innovación educativa, en el centro de Imaginar Futuros
Eafitenses en CTeI EAFIT exalta la labor de sus científicos
Hablemos de CTeI
El reto de ser Distrito Especial de Ciencia, Tecnología e Innovación
18 36
14 30
Portada Energética 2030, en busca de futuro
40 48
Jóvenes investigadores Saber para Sanar, apuesta por un mejor país
Ciencia en imágenes Talaromyces santanderensis: un nuevo hongo tolerante al cadmio de suelos de cacao en Colombia
EAFIT investiga Inversión privada en el acceso a la justicia
56 10 26 52
Opinión Por una transición energética responsable
Ciencias para niños
Descubre tu entorno con esta guía de observación de flores y polinizadores
Apreciados lectores de la Revista Universidad EAFIT “Descubre y Crea”,
Es un gusto poder dirigirme a ustedes nuevamente a través de esta nota editorial, de un número de la revista que no solamente marca un giro importante en enfoques, contenidos y formatos, como ventana a la actividad científica e investigativa que realiza nuestra comunidad eafitense, sino también como reflejo del proceso de transformación institucional en el que nos encontramos, incluyendo el de nuestro sistema de Ciencia, Tecnología e Innovación (CTeI).
Como bien lo apuntábamos en nuestro número anterior, la transformación del sistema de CTeI se fundamenta en una concepción integral de las Actividades de Ciencia, Tecnología e Innovación (ACTI) que realizamos en EAFIT, que buscamos que se articulen de una manera horizontal e interdependiente, es decir, que nuestro éxito en una de estas actividades –como lo es la investigación– necesariamente dependa del éxito en las demás. El nombre que ahora lleva por más de un año nuestra Vicerrectoría de Ciencia, Tecnología e Innovación es símbolo de una transformación que continúa liderando nuestra rectora, Claudia Restrepo, y que se ha dado de la mano con transformaciones paralelas en Escuelas, Centros de Estudios e Incidencia, y otras áreas de soporte, entre muchas dependencias que trabajan por el fortalecimiento de nuestro sistema de CTeI.
Y en el centro de todo este trabajo sigue estando siempre nuestra gente, nuestra comunidad eafitense que dinamiza y genera impacto en nuestra sociedad, al tiempo que individualmente crecen en su propia ruta del conocimiento”.
Entre muchos avances importantes, es de especial agrado compartir la creación del Laboratorio de Divulgación Científica, como área adscrita a la Vicerrectoría de CTeI, y que desde un conocimiento profundo y sistemático de la actividad científico-tecnológica de la universidad busca visibilizar ante públicos externos e internos, la diversidad, la importancia y la sofisticación de estos avances. Como lo hemos declarado en nuestro propósito, buscamos poner la ciencia en el corazón de todos. Más que generar cierto número limitado de productos sin una conexión coherente ni un propósito superior, la misión de esta área será la de generar estrategias a través de la conjunción de recursos comunicativos que atraigan a una gran variedad de públicos, y se conviertan en una fascinante puerta a la Apropiación Social del Conocimiento.
La imagen de esta transformación en enfoques y visiones en nuestra estrategia de divulgación científica se refleja en este número de Descubre y Crea, en el que de manera intencionada mostramos desarrollos y perspectivas en cada una de las actividades comprendidas en nuestro sistema de CTeI: Investigación, Desarrollo Tecnológico e Innovación, Apropiación Social del Conocimiento y Formación en CTeI. Sumado a esto, incluimos perspectivas a nivel transversal y sistémico, como las relacionadas con el desarrollo del Distrito de
Ciencia, Tecnología e Innovación de Medellín, un proyecto de ciudad en el que como EAFIT hemos buscado tener un rol de liderazgo, en línea con nuestro compromiso con el desarrollo del sector en la ciudad, la región y el país. De esta manera, los cientos de proyectos de CTeI que como institución desarrollamos cada año, y de los que este número sólo recoge una muestra representativa, se comprenden como la materialización de una estrategia coherente y ambiciosa, de naturaleza transdisciplinar, y que busca ser más que la suma de sus partes.

Y en el centro de todo este trabajo sigue estando siempre nuestra gente, nuestra comunidad eafitense que dinamiza y genera impacto en nuestra sociedad, al tiempo que individualmente crecen en su propia ruta del conocimiento. Desde los niños, niñas y adolescentes que participan en la Universidad de los Niños y son nuestros primeros investigadores, hasta los profesores que con su pasión y excelencia producen resultados transformadores en la frontera del conocimiento de sus respectivas disciplinas, de cara a nuestra sociedad y a las organizaciones con las que trabajamos, al tiempo que forman las próximas generaciones de profesionales e investigadores.
Reciban un cordial saludo, con el deseo sincero de que disfruten de este número tanto como nosotros hemos disfrutado en hacerlo.
Antonio Copete Vicerrector de Ciencia, Tecnología e InnovaciónMicroalgas para capturar CO2, bacterias para salvar la producción de banano y un proyecto para mejorar la producción de caucho son tres grandes apuestas incubadas en los laboratorios de la Universidad EAFIT.
Por Pablo Correa, colaboradorEl vino, el pan y la cerveza son tres de los ejemplos más cotidianos, antiguos, exquisitos, de la creatividad humana para manipular organismos vivos con el objetivo de crear o modificar algún producto. En una palabra, tres ejemplos de lo que hoy pomposamente llamamos “biotecnología”.
Pero esos primeros ancestros nuestros que dominaron la fermentación con bacterias quedarían boquiabiertos de lo lejos que han llegado sus sucesores en esta ciencia: vacunas con RNAm, alimentos transgénicos, bacterias para producir insulina, microorganismos para descontaminar aguas, tratamientos contra el cáncer y la lista sigue creciendo día tras día.
“La biotecnología tiene el potencial de al terar muchos aspectos de la vida humana y los transformará de formas que no podemos imaginar”, pronosticaban el año pasado los editores de la revista Nature Biotechnology
Y eso es, justamente, lo que desde hace más de una década intentan hacer varios gru pos de investigación en la Universidad EAFIT: descubrir e imaginar usos de la biotecnología para solucionar problemas en nuestro país.
Tres de los proyectos más exitosos incuba dos en los laboratorios de EAFIT dejan varias enseñanzas para seguir apostando por la bio tecnología nacional. Se trata de la producción de algas para capturar CO2, el uso de bacte rias como agentes biológicos contra el hongo Sigatoka, que afecta la fruta del banano, y la producción de un mejor caucho natural en el Bajo Cauca antioqueño.
Las tres apuestas comparten algunos rasgos: se trata de esfuerzos de investigación enfocados en problemas reales e importantes para la economía nacional. También se han planteado como proyectos de mediano y largo plazo que no quedan estancados en la publicación de resultados, sino que aspiran dar el salto de las pruebas pilotos al escalamiento industrial. Además, han aglomerado a investigadores de distintos niveles, desde pregrado hasta doctorados, bajo la tutela de investigadores de pri-

La industria cementera en el mundo es una de las mayores responsables del calentamiento global al aportar cerca del 10% del dióxido de carbono. Preocupados por encontrar formas de reducir sus emisiones de gases de efecto invernadero, representantes de Argos, la mayor empresa de este sector en Colombia, se acercaron a EAFIT en 2009 en busca de ayuda.

Fue así como se comenzó a tejer una cadena de investigaciones que se han entrelazado para responder al reto utilizando microalgas. El primer paso consistió en identificar la especie con la que trabajarían. Las microalgas no solo crecen hasta 10 veces más rápido que una planta terrestre, sino que pueden ser hasta 50 veces más eficientes fijando CO2. El siguiente paso consistió en construir los primeros bioreactores, donde crecerían y harían su trabajo las microalgas. Gracias a que estos microorganismos acumulan lípidos en su interior es posible procesarlos mediante procesos químicos para convertirlos en biocombustibles.
Tras demostrar que el proceso era viable, se construyó una primera planta experimental en la ciudad de Cartagena. Aquí apareció un reto mayor: aunque se había demostrado la viabilidad del proceso, el modelo financiero no era viable. Los costos de producción de microalgas rondaban los $210 por kilogramo y un barril del biocrudos producido sobrepasaba los USD 88. Investigadores de la Universidad de Antioquia se sumaron al proyecto para buscar puntos de optimización y, finalmente, pudieron demostrar que podían reducir el precio por barril a USD 38, además de mejorar la calidad del biocrudo. En este punto, la empresa estatal Ecopetrol ya ha mostrado su interés, se logró una patente del procedimiento y ganaron el Premio Alejandro Ángel Escobar en la categoría ambiental.
Alex Sáez Vega, investigador de EAFIT, explica que, como el uso de microalgas para captura de CO2 no es rentable por sí mismo, “la idea es sacar todas las ventajas posibles de esa biomasa para balancear la ecuación económica”. Por esto, además de biocombustibles, están haciendo ensayos para usar las microalgas como trampas de material particulado en las ciudades y también como biofertilizantes.
Hace 15 años, la Universidad EAFIT, la Asociación de Bananeros de Colombia (Augura), el Centro de Investigaciones del Banano (Cenibanano) y la empresa Forbio sellaron un convenio para enfrentar juntos uno de los problemas que más atormenta a los bananeros: la Sigatoka Negra, la enfermedad más destructiva y de mayor valor económico en los cultivos de banano y plátano, causada por el hongo Mycosphaerella fijiensis. Se estima que puede reducir hasta en un 50% el peso del racimo y causar pérdidas del 100% de la producción, debido al deterioro en la calidad.
“Es una enfermedad que se controla con muchos fungicidas, lo que aumenta los costos de producción. Además, los bananeros estaban preocupados por las crecientes prohibiciones para el uso de esos fungicidas”, cuenta Valeska Villegas, investigadora principal del proyecto y quien ha guiado toda una red de colaboradores y científicos en busca de alternativas biológicas para controlar la Sigatoka Negra.
El primer paso fue salir en busca de bacterias presentes en los cultivos de banano y que manifestaran alguna actividad antifúngica. En esa tarea aislaron más de 1.500 bacterias de las raíces y hojas de las plantas, y mediante un proceso de bioprospección identificaron las de mayor potencial.
Finalmente, el ADN de la bacteria con mayor potencial (Bacillus subtilis EA-CB0015) fue secuenciado y se identificaron las moléculas que producía. Uno de esos compuestos (Fengycin C) se constituyó en la base de un nuevo bioproducto que combate la enfermedad. En las pruebas de campo se comparó su efectividad frente a fungicidas como el Clorotalonil y Mancozeb, dos de los más populares entre los bananeros, y se demostró que eran equivalentes.
Curiosamente, los mayores obstáculos para la profesora Villegas no han estado del lado de la ciencia, sino de la burocracia legal, que ha implicado una alta inversión de tiempo para lograr registros, autorizaciones y patentes. La empresa Forbio ya comenzó el escalamiento de la producción.

En el Bajo Cauca antioqueño, más de 1.200 familias dependen de la producción y comercialización de caucho natural. Sus cultivos se extienden por más de 4.300 hectáreas. Pero tanto la Asociación de Cultivadores de Caucho (Asculticaucho), en el municipio Tarazá, como los encargados de la planta de producción Rubbercorp, en Caucasia, tenían claro cuando se acercaron a la Universidad EAFIT que su permanencia en un mundo tan competitivo dependía de elevar la calidad del caucho producido, así como los procesos industriales asociados.
Ahí entraron en escena varios investigadores de EAFIT: algunos se concentraron en el diagnóstico y las técnicas para el sangrado del árbol de látex, así como en el uso de estimulantes para aumentar la producción; mientras otros investigaron formas de mejorar la deshidratación y coagulación del caucho usando elementos y especies locales con el fin de facilitar su transporte.

El profesor Carlos Rodríguez Arroyave y otros colegas concentraron esfuerzos en mejorar el proceso industrial para elevar la calidad de las láminas producidas y, además, hacerlas menos alergénicas.
Elizabeth Rendón, coinvestigadora, aclara que un componente fundamental de todo el proyecto ha sido apostar por la transferencia de conocimiento de la academia hacia las
comunidades: “Estamos hablando de un conocimiento complejo y queríamos cerrar la brecha, así que trabajamos con cultivadores y rayadores y desarrollar una manera más efectiva de transferir conocimiento”.
Otro proceso que ayudaron a mejorar fue el aprovechamiento de los residuos del látex de caucho centrifugado de la planta Rubbercorp. Este material, en el que se pierde entre el 4% y el 10% del caucho recolectado por los productores, se convirtió en la materia prima de nuevas láminas mediante un proceso de coagulación y secado.
“Obtuvimos un caucho terminado de altas especificaciones técnicas en cuanto alto índice de elasticidad, con menores cantidades de proteínas, nitrógeno, cenizas y volátiles. Un producto que tiene altas probabilidades de uso”, comenta Rodríguez.
Adicional a todo ello, se está trabajando en la implementación de un horno con energía solar para el secado del caucho.
Grupo de caucheros en los laboratorios de la Universidad EAFITLa biotecnología tiene el potencial de alterar muchos aspectos de la vida humana y los transformará de formas que no podemos imaginar”.
Revista Nature Biotechnology.

Atender la inquietud de uno de los grandes grupos del sector comercial del país llevó a varios investigadores de la Universidad EAFIT a crear un método de medición y gestión del impacto que este tipo de empresas tiene en la sociedad. El propósito ahora es aplicarlo a diversas instituciones.
Por Juan Diego Restrepo E., colaboradorMedir el impacto en la sociedad es una aspiración que tienen aquellas organizaciones que ven más allá de las simples transacciones de compraventa de servicios y productos. Para aquellos que tienen claro ese objetivo, los balances de pérdidas y ganancias no son suficientes para expresar sus resultados, sobre todo cuando tienen programas que le añaden valor a sus labores.
¿Cuánto aportan socialmente aquellas iniciativas que impulsan las organizaciones, relacionadas con la nutrición infantil, la formación de los jóvenes y el comercio sostenible, por reseñar algunas de ellas? ¿Y cómo se reflejan ese tipo de intervenciones en su reputación y sostenibilidad?
Preguntas como esas gravitaban alrededor del Grupo Éxito, un conglomerado del sector comercial de grandes superficies que tiene entre su portafolio varios programas que promueve entre empleados, proveedores y clientes. Se trata con ello de generar nuevas oportunidades y de aportar al crecimiento del país.
Para resolver esas dudas, el grupo empresarial, bajo el liderazgo de su gerente general, Pablo Montoya Dávila, buscó respuestas en la Universidad EAFIT. Su propósito era que investigadores de diversas disciplinas les ayudaran
¿Cuál es el retorno para la sociedad de las iniciativas sociales y ambientales de la compañía y en cuáles estratégicamente deberían enfocarse?”.
a medir los impactos, tanto positivos como negativos, de sus iniciativas sociales con el fin de mejorar procesos y ser más asertivos en sus decisiones.
De esa búsqueda surgió Bien Plus (o Bien+), un modelo de medición del valor del bien público de las organizaciones creado por diez investigadores de diferentes áreas del conocimiento en su proceso de darle respuestas claras a las preguntas que tenían en el Grupo Éxito sobre sus iniciativas sociales.
La pregunta de la que partieron fue la siguiente: ¿cuáles el retorno para la sociedad de las iniciativas sociales y ambientales de la compañía y en cuáles estratégicamente deberían enfocarse? Para responderla, se conformó un grupo interdisciplinario integrado por profesores y estudiantes asistentes de los programas de Administración y Economía, liderados por el profesor emérito, Jesús Botero, y la jefe de la Maestría en Sostenibilidad, María Alejandra Gonzalez-Perez, y comenzó a trabajar bajo un proyecto cofinanciado por el Grupo Éxito y la universidad.
Las inquietudes de este conglomerado comercial reflejan la importancia que ha cobrado el concepto de sostenibilidad empresarial y sus iniciativas de cara a la sociedad, que el Grupo Éxito promueve a través de iniciativas que generan valor, “con el propósito de nutrir de oportunidades a Colombia a través de la promoción del crecimiento económico, el desarrollo social y la protección ambiental”, se lee en su sitio web.
Dada esa especial relevancia, se creó la necesidad de medir los impactos de las iniciativas que promueven para identificar no solo qué se está haciendo bien o mal, sino aquello que esté dando un mejor valor público para optimizar sus procesos y ampliar sus beneficios.
El grupo de trabajo –cuenta Mery Tamayo, profesora e investigadora del área de Mercados y Estrategia Financiera– se articuló con el equipo de Sostenibilidad del Grupo Éxito y se inició un proceso de diseño de la investigación, seguido por la recolección de datos primarios con las diferentes áreas de esa organización, para responder las preguntas que se habían planteado.
Poco a poco se fue consolidando el proceso de investigación y la creación del modelo de medición y gestión Bien Plus, que se define como “un modelo de medición del valor público generado por las organizaciones como un instrumento de evaluación y orientación de la estrategia de sostenibilidad”.
Después de varios meses de trabajo, se lograron resolver varias de las inquietudes del Grupo Éxito y sus hallazgos se le presentaron a la junta directiva. Ahora, se plantea avanzar en una segunda fase del proyecto, en la que se deben abordar nuevas mediciones y fortalecer el equipo investigador.
“Los resultados de esta investigación tienen el potencial de promover la gestión sostenible y permitir usar criterios de valor social al elegir, negociar, aliarse o favorecer a determinados socios o programas”, resume un documento de presentación de Bien Plus.
Los resultados alcanzados por el grupo de investigadores de Bien Plus fueron entregados al Grupo Éxito, pero el método desarrollado quedó bajo la tutela de EAFIT. Su adaptabilidad a diferentes contextos lo hace versátil y susceptible de ser aplicado “en diferentes países, pues al aplicar datos y estadísticas macroeconómicas de cada país con las particularidades de cada organización, permite obtener unos resultados más precisos”, se lee en uno de los documentos del proyecto.
Es un modelo de medición y de gestión que se fortalecerá con nuevas aplicaciones, y que, de generalizarse, permitirá consolidar un marco de referencia integral para el análisis del impacto que una organización tiene sobre la sociedad y la naturaleza. “Hasta ahora no se ha aplicado a otras empresas –agrega la investigadora Tamayo– pero esa es la intención que tiene la universidad. En la medida que se aplique a más organizaciones, se valida más el método y se pueden hacer comparaciones”.
Adicional a su proyección empresarial, Bien Plus se ha convertido en un aporte valioso de EAFIT en otros aspectos, de acuerdo con informes que resumen el proyecto: "Ha vinculado conocimientos interdisciplinarios, ha fomentado la formación de investigadores jóvenes en el equipo de trabajo y busca consolidar una comunidad académica en la región, pues ha realizado algunas discusiones sobre el tema con pares académicos de algunas universidades públicas y privadas”.
Hay una fuerte expectativa por seguir desarrollando este modelo. “Si la universidad lograra hacer este trabajo más sistemático, tendría mucho valor”, resalta Tamayo. “Es un ejercicio muy bonito: es aplicar la academia a temas empresariales; es una cuestión multidisciplinar; es un desarrollo de una metodología en una universidad que puede ayudar a las empresas; y porque podríamos hacerlo más universal”.
Por ahora, desde EAFIT se trabaja en lograr la patente de Bien Plus y, además, se reflexiona internamente en el grupo de investigación en qué tendrían que hacer para volverse más eficientes y ofrecerla a más organizaciones para contribuir en la optimización de sus iniciativas y ayudarles a priorizar cuáles serían los programas que les generaría más rentabilidad y reconocimiento social.
En resumen, se plantea en uno de sus informes que este modelo de evaluación “constituye una apuesta innovadora desde la academia [y] permite evidenciar la contribución integral y social de las organizaciones, su rol como promotoras del desarrollo, y los efectos reales de sus actividades de ciudadanía corporativa”.
Bien Plus adquirió notoriedad en agosto del año pasado tras ser reconocido por Proantioquia con el galardón Nicanor Restrepo Santamaría que se le otorga a todos aquellos grupos y organizaciones que realizan aportes significativos al desarrollo y a la transformación de la sociedad. Esa distinción se le otorgó a Jesús Botero, Maria Alejandra Gonzalez-Perez, Mery Patricia Tamayo Plata, Luz Maria Rivas Montoya, Sandra Constanza Gaitán Riaño, Henry Daniel Puerta Álvarez, Mario Enrique Vargas Saénz, Maria Camila Vargas de la Hoz, Isaac Hurtado Rivera y Carlos Felipe Munera Alzate.
Hasta ahora no se ha aplicado a otras empresas, pero esa es la intención que tiene la universidad. En la medida que se aplique a más organizaciones, se valida más el método y se pueden hacer comparaciones”.
Mery Tamayo, profesora e investigadora del área de Mercados y Estrategia Financiera de EAFIT.
Esa condición implica grandes desafíos para Medellín, que van desde nuevos diseños de gestión pública, fortalecimiento de alianzas público–privadas y herramientas de financiación, hasta hacer realidad un nuevo modelo de desarrollo basado en ciencia, tecnología e innovación, integral e incluyente, y con repercusiones de orden nacional.
Por Antonio Copete, vicerrector de Ciencia, Tecnología e Innovación. Tatiana Guerrero, colaboradora
Pocos ciudadanos probablemente conocen que, según la Constitución de Colombia, Medellín ostenta la calidad de Distrito Especial de Ciencia, Tecnología e Innovación. Lo es desde el 14 de julio de 2021, fecha de adopción del Acto Legislativo 01, que la consagra como tal. ¿Qué significa esto para la ciudad y para Colombia? ¿Cuáles son las oportunidades que esta condición representa para el futuro de la capital antioqueña y del sector Ciencia, Tecnología e Innovación (CTeI) a nivel local, regional y nacional?
Como aporte a la discusión de estas y otras preguntas, la Universidad EAFIT fue sede del Foro Medellín Distrito Especial de Ciencia, Tecnología e Innovación, que tuvo lugar el 9 de marzo de este año, y que contó con el apoyo del Comité Universidad-Empresa-Estado (CUEE) de Antioquia y del G8+ Universidades1 .
Ese evento se planteó como una discusión pluralista y con perspectiva de ciudad, pues el Distrito sólo tendrá éxito en la medida que sus ciudadanos y sus instituciones se apropien de él y aporten activamente en su construcción. Este artículo busca recoger hitos clave sobre el desarrollo del Distrito hasta el momento, así como algunas perspectivas expresadas por los especialistas que participaron en el Foro.
A la declaratoria de Medellín como Distrito de CTeI en 2021, le siguió un trabajo normativo en el Congreso de la República que culminó con la adopción de la Ley 2286 el 12 de enero de 2023, que crea una estructura de gobernanza y entrega un conjunto de herramientas con miras a hacer efectiva la condición de Distrito de CTeI, algunas de los cuales destacamos aquí.
En primer lugar, se crea el Organismo Asesor del Sistema de Ciencia, Tecnología e Innovación Distrital, que es la “instancia de asesoramiento a las autoridades del Distrito para la implementación del Sistema de Ciencia, Tecnología e Innovación”.
Esa instancia consta de un mínimo de doce (12) miembros, incluyendo representación de la academia. Está llamado a ser el órgano que emita recomendaciones a las autoridades distritales sobre estrategias y prioridades en materia de CTeI, vigile el funcionamiento del Distrito, y haga advertencias cuando sea necesario aplicar correctivos.
Otra de las herramientas establecidas, muy llamativa para las instituciones que desarrollan actividades de CTeI, serán las Zonas de Tratamiento Especial, en las que se buscará “fortalecer y facilitar el desarrollo de todo tipo de actividades de Ciencia, Tecnología e Innovación”.
Según lo reglamenten las autoridades distritales en cabeza del Concejo Distrital, en estas Zonas se podrían facilitar procesos que hoy dificultan el crecimiento de los emprendimientos de base científico-tecnológica o spin-offs, la utilización de equipos e insumos necesarios para llevar a cabo procesos de investigación y desarrollo tecnológico, y la formación de capital humano en todos sus niveles y su inserción en el entorno laboral, entre otras posibilidades.
En cuanto a herramientas de tipo financiero, se destaca la creación del Fondo Distrital para la Financiación del Sistema de Ciencia, Tecnología e Innovación, que puede recibir recursos de entidades del orden nacional, así como “recursos económicos públicos o privados, de cooperación internacional, donaciones u otras modalidades, para la financiación de programas
1. Universidad de Antioquia, Universidad Pontificia Bolivariana, Universidad Nacional sede Medellín, Universidad EIA, Universidad CES, Universidad de Medellín, Corporación Universitaria Lasallista, y con la participación del Instituto Tecnológico Metropolitano ITM.
y proyectos de interés científico, tecnológico y de innovación para el Distrito”.
Otros instrumentos de este tipo incluyen los estímulos tributarios para empresas de base tecnológica instaladas en el Distrito, la nueva Estampilla Pro-Innovación y el acceso directo a recursos de cooperación internacional.
Al mismo tiempo, sobre estos estímulos, el profesor y director de Desarrollo Económico y Social de ProAntioquia, Alejandro Torres, advierte que “los incentivos tributarios son importantes pero no son definitivos al final del día. Si no están acompañados de un ecosistema real de CTeI, terminan siendo accesorios, y pueden terminar erosionando el presupuesto del Distrito”.
Es importante también crear consciencia sobre las implicaciones de este proceso de construcción en el nivel nacional. El vicerrector de CTeI Antonio Copete apunta que “Antioquia da ejemplo sobre lo que se podría y se debería hacer en el resto del país en desarrollo de capacidades en CTeI”, y el viceministro de Conocimiento, Innovación y Productividad de Minciencias, Sergio Cristancho, agrega que “el Distrito sería un escenario ideal como sand-box regulatorio, en el que se podrían explorar y probar muchas políticas a nivel nacional”.
Existen múltiples aspiraciones y desafíos de acuerdo con lo expresado por los panelistas del Foro del Distrito de CTeI, y que se pueden abordar a través de los ejes Academia, Empresa, Estado y Sociedad.
Para el Estado, representado en el encuentro académico por la Alcaldía y el Concejo Distrital, una parte importante de sus responsabilidades se centran en el desarrollo e implementación de la política distrital de CTeI, la reglamentación de las herramientas que contempla la Ley 2286, y la generación de las condiciones que el Distrito requiere a través de marcos de política como el de innovación transformativa.
Al respecto, Santiago Echavarría, director del Centro de Ciencia y Tecnología de Antioquia (CTA), destaca la importancia de acompañar esas políticas de largo plazo con planes de CTeI que se renueven cada tres o cuatro años, y que contengan metas e indicadores muy claros, que se midan constantemente.
Desde la Academia, el Vicerrector de Extensión de la Universidad de Antioquia, David Hernández, enfatiza la discusión social aplicada sobre la discusión jurídica: “Somos Distrito porque Medellín es una fuente fructífera de creatividad, emprendimiento y patentamiento”. Y agrega que las universidades han cumplido un rol fundamental en el desarrollo de esta vocación.
Hernández resalta la importancia de las universidades en la educación precedente, es decir, en la asesoría a instituciones educativas para incentivar la creatividad y la innovación desde las edades más tempranas.
Desde el punto de vista empresarial, Yaneth Londoño, CEO de la firma textil Offcorss, y Catalina Isaza, creadora de la spin-off de dispositivos médicos Innmetec, coinciden en resaltar la importancia de los impactos del Distrito en el desarrollo de talento humano, y en el fortalecimiento de conexiones en el ecosistema de Medellín, entre emprendedores, las grandes empresas, la universidad y el Estado.

Londoño subraya la importancia de los incentivos fiscales para las pequeñas y medianas empresas, que enfrentan muchas dificultades a la hora de invertir en innovación y mejoramiento de la productividad, y asegura que el sector textil puede hacer grandes innovaciones en temas como el desarrollo de fibras y nuevos materiales que se pueden potenciar a través de las herramientas del Distrito.
Por último, como voz de la sociedad civil organizada, Javier Márquez, cofundador de la Corporación Ecológica y Cultural Penca de Sábila, expresa sus preocupaciones por las crisis de tipo social y ambiental que afronta el Distrito, y hace un llamado a tener una visión integral del territorio, para que sus instrumentos beneficien y sean aprovechados por sectores sociales como las comunidades étnicas y campesinas que son parte integral de la ciudad.
El establecimiento del Distrito y sus herramientas abren una ventana de oportunidad para una transformación real basada en la ciencia, la tecnología y la innovación. Está en manos de todos como ciudadanos y como instituciones asumir la responsabilidad de aprovecharla, y que se convierta en un modelo de desarrollo innovador para todo el país.
“Somos Distrito porque Medellín es una fuente fructífera de creatividad, emprendimiento y patentamiento. En las aulas, en los grupos de investigación, en las empresas hay una apuesta seria por la innovación”.
David Hernández, vicerrector de Extensión U de AntioquiaRevive el Foro: Medellín Distrito Especial de Ciencia, Tecnología e Innovación.
Tres semilleros de la Universidad EAFIT se unieron para idear y desarrollar este proyecto de investigación-creación en el que se exhiben 13 objetos inútiles de manera articulada con 13 obras musicales, acompañados, cada uno, de una microficción literaria. La iniciativa tiene su origen en el cuento de la escritora uruguaya Cristina Peri Rossi, El museo de los esfuerzos inútiles, escrito en 1983. En 2023 esperan instalar la exposición en Medellín y El Retiro.
Por Juan Carlos Luján Sáenz, colaborador
¿Tendrá utilidad una trapeadora con cerdas de acero?, ¿o quizás un levantador de meñique?, ¿o qué tal intentar comerse una torta de tiza?, ¿o protegerse con un casco frágil? Todo esto es posible en el universo de lo inútil, o bueno, en el Museo de los Esfuerzos Inútiles, un proyecto en el que se encuentran la música, la literatura y la escultura, una crítica que en palabras del profesor Rodrigo Henao Arango, del
Sala de estar
Departamento de Música de la Universidad, le apunta al por qué todo debe ser útil o servir para algo.
En este escenario de lo inútil convergieron los semilleros Musux, de investigación artística y adscrito al Departamento de Música; Sin-H, de investigación en narrativa y hermenéutica literaria, que hace parte del pregrado en Literatura; y Errante, del programa de Ingeniería de Diseño de Producto.
Tensión entre lo perfecto e imperfecto. Apariencia de orden y control.

de acero
El esfuerzo inútil de la pulcritud.
Casco frágil

El esfuerzo inútil de proteger y protegerse.
Kit MatscotaEl esfuerzo inútil de buscar relaciones no conflictivas.

Según el catálogo de esta iniciativa, “se trata de un trabajo interdisciplinar en el que los semilleristas experimentan en conjunto con técnicas de investigación-creación y procuran el descubrimiento de espacios novedosos de percepción e ideación”. Su propósito es “sumergir al visitante en una experiencia sensorial y cognitiva que lo involucre en reflexiones e imaginaciones sobre la utilidad e inutilidad de muchas prácticas, deseos y proyectos humanos”. Hasta el momento son trece la cantidad de objetos, piezas musicales y relatos de microficción que integran esta instalación, inspirada en el cuento El museo de los esfuerzos inútiles, de la escritora uruguaya Cristina Peri Rossi (Seix Barral, 1983), una obra que reflexiona sobre el hombre y todas sus inventivas y propósitos. “Es muy curioso que los esfuerzos inútiles se repitan […] Un hombre intentó volar siete veces, provisto de diferentes aparatos; algunas prostitutas quisieron encontrar otro empleo; una mujer quería pintar un cuadro; alguien procuraba perder el miedo; casi todos intentaban ser inmortales o vivían como si lo fueran”, se lee en uno de sus apartes.
Y justo ese tipo de reflexiones llevaron a los creadores de esta iniciativa en EAFIT a concebir una exhibición en espacios que corresponden a cuatro lugares de la vivienda familiar tradicional: sala de estar, baño, biblioteca y dormitorio.
La sala de estar, por ejemplo, apela a la tensión entre lo perfecto y lo imperfecto, a representar una apariencia de orden y control. Esta cuenta con tres objetos: kit Matscota, el esfuerzo inútil de buscar relaciones no conflictivas; la trapeadora con cerdas de acero, el esfuerzo de lo inútil de la pulcritud; y el casco frágil, el esfuerzo inútil de proteger y protegerse.
Y en el baño se encuentran el monóculo de sol, el levantador de meñique y la sombrilla, como expresiones de una “búsqueda de lo que no está a la vista”; en la biblioteca, concebida como el espacio donde chochan “la apariencia y los deseos auténticos”, se ubican el reloj aleatorio, una calculadora sin operadores y la torta de tiza. Mientras que en el dormitorio, donde se suprime toda regla, se tienen una máscara transparente, un condón de encaje, unas zapatillas para sin correr y un juego de té poroso.
Orden que enmascara lo íntimo, Invita a la búsqueda de lo que no está a la vista.
El esfuerzo inútil de tapar
el sol con un dedo.
El esfuerzo inútil de aparentar por encajar.


El esfuerzo inútil de buscar estar cómodo siempre.

El profesor Rodrigo Henao es uno de los gestores de este proyecto. Cuenta que lo pensaron hace cerca de dos años y que a partir de las obras musicales que su semillero creó, los de Ingeniería de Diseño de Producto planearon un objeto. A su vez, los de Literatura le hicieron una especie de curaduría a cada elemento, y, de esta manera, le dieron vida a algo así como un manual de instrucciones irónica, “un manual de uso, un poco simpático, porque obviamente una cosa inútil no tiene uso, pero ellos le dieron su uso”.
Henao explica que en Ingeniería planearon la parte museográfica. “Somos un proyecto muy artístico. Nosotros, por ejemplo, componemos música como inmersiva. Nuestra música está diseñada para ser ‘espacializada’, el público está en la mitad y así ocurre en esta presentación. Los objetos están distribuidos en la sala y cuando alguien entra se ilumina un objeto y suena la música de dicho objeto, a la vez que se ve el cuento”.
¿Y los nombres de las obras musicales? En la misma línea de los objetos: Carta al tiempo, Predecir lo impredecible, Cirugía plástica, El esfuerzo de lo inútil, Enamorarse, Traducir sentimientos, Dormir dentro del arpa de un piano, Vivir en un sueño, Volver sobrio al adicto, Lo inútil de hacer lo útil, Libertaria y Lo inútil de hacer arte. Todas creaciones de estudiantes y de profesores del Departamento de Música de EAFIT.
Y reitera el docente: “Mi obra es la inutilidad del arte, porque si uno se pone a pensar, un cuadro no sirve para nada, la música tampoco sirve para nada, es que fuera de la parte estética, uno no puede hacer nada con eso (risas). Y lo mismo la literatura, porque si uno habla de ficción hasta está hablando de mentiras. Es muy filosófico esto, es reivindicar esa parte de lo inútil, que es volverlo útil. Es darnos cuenta de que a veces lo útil puede ser más inútil”.
Siguiendo con el catálogo, y en línea con la percepción de Henao, “la idea es que a través de materializaciones objetuales, sonoras y textuales se active un ánimo exploratorio en torno al sentido de muchos esfuerzos vitales e, incluso, en torno a la necesidad de acoger lúcida y estéticamente su sinsentido”.

¿Sinsentido? Como se diría en el barrio, ‘se le tiene’. Se trata del Levantador de meñique, sobre cuyo uso escribe Matilda Lara: “Para hacer uso de su levantador de dedo, introduzca el dedo meñique en el objeto y acomódelo en la última falange como si fuese un anillo. Luego, compruebe que el objeto funciona correctamente intentando flexionar su dedo. Si se mantiene inmóvil, funciona. De lo contrario, puede que esté defectuoso o que la talla deba ajustarse. De ser así, por favor comuníquese con nosotros”. Así comienza este pequeño relato de ficción, titulado Levantador de meñique, y que acompaña la obra musical Cirugía plástica, de Ana Valencia.
Orden que enmascara lo íntimo, Invita a la búsqueda de lo que no está a la vista.


El esfuerzo inútil de medir el tiempo.
Calculadora sin operadores
El esfuerzo inútil de comprender el universo por medio de la abstracción.
El esfuerzo inútil de hacerlo todo un espectáculo.
El docente Nicolás Peñaloza Hoyos, del pregrado en Ingeniería de Diseño de Producto, creó el semillero Errante que ha contado con la participación de unos 16 estudiantes, además de egresados y otras personas cercanas a este programa.
Cuenta Peñaloza que para este proyecto del Museo de los Esfuerzos Inútiles comenzaron a hacer la conceptualización a partir de las obras, reflexionando sobre el sentido de la inutilidad y la utilidad, y más en Ingeniería, en la que la utilidad es un principio fundamental.
“Nos salimos, entonces, de ese paradigma ingenieril de que las cosas tienen que servir para algo, y básicamente hicimos una lluvia de ideas de objetos inútiles para hacer un match entre la conceptualización de los esfuerzos y los objetos que se nos ocurrieron”, explica el docente.

De ese ejercicio surgieron 12 objetos inútiles. “Por ejemplo, tenemos un juego de té que no sirve para preparar té porque es poroso. Entonces representa el esfuerzo inútil de contenerse. Yo he sido como una especie de guía del proceso, de hecho, los objetos han surgido de los estudiantes”.
Tras la etapa de ideación viene la de desarrollo y de darle forma a esas conceptualizaciones: “Y seguimos con los ejemplos: a vos se te ocurre que para hacer una crítica al esfuerzo inútil de querer hacer de todo un acontecimiento vital, vamos a hacer una torta. Así, hay
que pensar bien en qué tamaño hacerlo, con qué materiales, meter la pata muchas veces… Intentamos con un material, luego con otro, hasta que tenemos la forma de todos nuestros objetos y se amplía a 13 objetos inútiles porque surge una obra musical más”.
Sí, es el esfuerzo de lo inútil. La idea en 2023 es hacer una instalación con varias galerías en la Casa de los Tres Patios (Medellín) y otra en El Retiro, pues tal como se indica en el catálogo, “toda la creación interdisciplinar ha sido pensada para ser exhibida en un espacio museográfico que propicie la conjunción de los tres tipos de productos: musical, literario –minificciones curatoriales– y materialización del esfuerzo inútil como objeto”.
De niños muchas veces la cantaleta de los papás se dirigía a eso: “Ustedes tienen que ser gente útil para la sociedad”. Útil claro, pero en el terreno del arte todo es posible, hasta de convertir algo inútil en útil. Y sí, ¿se imaginan qué habría sido de la vida durante la reciente pandemia de no haber sido por tanta cosa “inútil” como la música o la literatura?
Escanéame para escuchar las Piezas musicales
Dormitorio
Supresión de la regla. Evoca e invita a la liberación (el espectador se vuelve actor).

El esfuerzo inútil de querer evitar que todo cambia con el tiempo.
Mácara transparente
El esfuerzo inútil de buscar ser auténtico.
Condón de encaje


El esfuerzo inútil de buscar que las acciones no tengan consecuencia.
Juego de té poroso
El esfuerzo inútil de contenerse.
La Universidad EAFIT hace parte de las instituciones que lideran el proyecto Efecto Cacao, mediante el cual se pretende mejorar la calidad de vida de cerca de 1.700 familias de cacaultores en cuatro regiones del país. Se espera una inversión de 35 millones de dólares, en dinero y especie, en tres componentes: productividad, asociatividad y emprendimiento, y social. Además, ha servido para la sustitución de cultivos de uso ilícito.
Por Juan Carlos Luján Sáenz, colaboradorEn leche o en agua, frío o caliente, en crema o en helado, en una chocolatina, en una bolita con algún dulce por dentro, dulce o amargo… Morderlo es experimentar la felicidad. Sí, todo ese sabor expandido por las papilas gustativas, segundos de una sensación de placer que o tranquiliza, o sana, o divierte, o activa. Este placer tiene nombre: el chocolate, el mismo cuyo origen se encuentra en el fruto del cacao, la planta originaria de América que se ha expandido a otros continentes y del que Colombia es uno de los principales productores en el mundo. El décimo para más señas.
Según cifras del Ministerio de Agricultura y Desarrollo Rural de noviembre de 2021, el año cacaotero de octubre de 2020 a septiembre de 2021 fue el más grande de toda la historia productiva del grano en Colombia con 70.205 toneladas producidas. En contraste, la Federación Nacional de Cacaoteros (Fedecacao), en comunicación emitida el 1 de noviembre de 2022, habló de un descenso en la producción por las intensas lluvias que han afectado al país. Esto entre octubre de 2021 y septiembre de 2022, con una baja del 10,6%.
Lo que sí muestran ambas cifras es una producción representativa que abarca a unos 15 departamentos, pero con un foco más activo en Santander, Antioquia, Arauca, Huila y Tolima. Además, como lo muestran algunas cifras de
Fedecacao en Colombia se han reemplazado con plantaciones de cacao por lo menos 25 mil hectáreas de cultivos ilícitos.
Y es ahí cuando es preciso referirse al proyecto Efecto Cacao, iniciativa en la que participan la Agencia de Estados Unidos para el Desarrollo Internacional (USAID), Luker Chocolate, Fundación Luker, Enel-Emgesa, Fundación Saldarriaga Concha y la Universidad EAFIT.
Se trata de una alianza que desde finales de 2018 hasta hoy (finaliza en septiembre de 2023), ha fortalecido la cadena productiva del cacao, a su vez que ha contribuido a mejorar las condiciones de vida de los productores, sus familias y sus comunidades en cuatro departamentos: Antioquia, Córdoba, Huila y Nariño. En estos lugares se les ha dado vida a 71 iniciativas empresariales y ha intervenido 1.340 hectáreas de cacao a través de 20 asociaciones. ¡Sí, unas 1.700 familias han sido las beneficiadas!
“Este es un proyecto con un enfoque de desarrollo local desde el punto de vista social y económico que le apunta a mejorar la calidad de vida de las familias de los cacaocultores de estas zonas”, explica la ingeniera administrativa Luz Marina Correa Zabala, consultora del proyecto.
“Estas zonas –agrega– tienen una característica común y es que han sido lugares expuestos históricamente a un alto conflicto de actores

armados de diferentes orígenes y ha habido mucho desplazamiento y violencia, y poco de desarrollo en el territorio por estas disputas. Y claro, la población está en el medio. Buscamos que tengan un mejor nivel de ingresos”.
Efecto Cacao hace presencia en los municipios de San Pedro de Urabá, Turbo, Necoclí, Apartadó y Cáceres (Antioquia); Puerto Libertador y Montelíbano (Córdoba); El Agrado, El Pital, Gigante, Hovo, Algeciras, Campo Alegre y Rivera (Huila); y Tumaco (Nariño).
“En estas zonas el promedio de edad de los cacaocultores es de 60 años en adelante, lo que significa que hay que hacer mucho énfasis en la inclusión generacional para que este cultivo no se pierda porque es ancestral. Es también el cultivo de la paz porque se han sustituido muchos cultivos de coca”, especifica la consultora.
Tal como lo explica esta especialista, es una lucha muy intensa en los territorios porque la coca les da la posibilidad de recibir dinero de inmediato, teniendo en cuenta que quienes controlan estos cultivos de uso ilícito manejan grandes sumas de dinero. No obstante, al hacer las cuentas en términos de rentabilidad, se encuentra que son muy similares, y si se trabaja un muy buen cultivo de cacao, este ofrece la posibilidad de tener un ingreso seguro por varios años.
Este proyecto, cuya inversión asciende a los 35 millones de dólares –entre dinero y especie– cuenta con tres componentes: Productivo, de Asociatividad y Emprendimiento, y Social.
El Productivo se enfoca en mejorar la calidad de vida del cacaocultor y generar desarrollo social y económico en el territorio a través de mejorar la productividad en términos de volumen de producción y calidad del cacao. Cuando el proyecto inició, la estadística que se tenía del ingreso promedio del productor era de medio salario mínimo mensual legal vigente.


Además, el reto es poder ofertar un cacao fino y de aroma, que es el que finalmente se exporta, por lo que se busca pasar del cacao corriente al cacao con las características ya mencionadas. Este componente está apoyado por un ingeniero agrónomo, un tecnólogo agropecuario o un tecnólogo agrónomo que visitan a los productores en sus fincas.
Por su parte, la Universidad, a través de EAFIT Social, se encarga del componente de Asociatividad y Emprendimiento. “Allí acompañamos el fortalecimiento organizacional de las asociaciones o cooperativas que agrupan a los productores. Las empresas, por ejemplo, no le compran directamente al productor, sino que lo hacen a una organización. Entonces las acompañamos en este tema, pero también en el de desarrollo de los emprendimientos porque la idea es propender que tengan varias fuentes de ingresos para que las familias puedan solventarse en los momentos en los que no hay cosecha”, afirma Correa.
El cacao, la esperanza de miles de familias campesinas.El tercero, el componente Social, se enfoca más en la población y en su recuperación, sobre todo en la más afectada por las violencias. Dentro de esas violencias se encuentra, por ejemplo, la de género, teniendo en cuenta que son poblaciones que viven inmersas en una cultura machista, sumado a los grupos al margen de la ley, que alimentan mucho más esa situación, relegando el papel de la mujer a labores del hogar o de la atención del hombre.
Con Efecto Cacao viene un enfoque de recuperación, junto con los niños, los jóvenes y los adultos. A su vez, se trabajan temas de resiliencia, liderazgo, empoderamiento de los jóvenes y de la mujer, de preparar a los jóvenes para la vida laboral, y de mejorar las condiciones académicas de los programas de los colegios de estas zonas.
En línea con lo anterior, Mario Vargas Sáenz, director de EAFIT Social, afirma que la Universidad, en desarrollo de la iniciativa con los cacaocultores, ha acompañado procesos de formación de más de 500 mujeres. “Sabemos que más del 50% de todas las personas que participan en las asociaciones que acompañamos son mujeres”, precisa.
De acuerdo con esta cifra, ningún componente podrá ser más importante, en proyectos de desarrollo rural o local, que el de fortalecimiento del tejido social, indica Vargas, y agrega que “identificar las capacidades de las
personas, fortalecer los vínculos de confianza y construir relaciones de sentido que trasciendan la productividad son fundamentales”. Por ello resalta que la esencia del tejido social es la dignidad de sus pobladores: “Eso es parte del impacto que el Efecto Cacao está derramando en las diferentes zonas donde se encuentra”.

Brindar con una taza de chocolate por la reivindicación de cientos de campesinos del país que encontraron un cultivo que les permitiera tener una forma digna de vivir y de construir sociedad es, en esencia, en lo que creyeron cinco instituciones y los resultados del proyecto pueden verse en la productividad y en las cerca de 1.340 hectáreas de cultivo intervenidas en los cuatro departamentos.
Y claro, hablamos de un producto que hace parte del diario vivir de los colombianos, quienes consumen por lo menos un kilo de cacao al año. ¡Ah!, pero es que también, en cualquier país del mundo donde se exporte el producto, estará presente la labor de unas familias que, a partir de resultados concretos, como fue la firma del Acuerdo de Paz en noviembre de 2016 entre el Estado colombiano y la extinta guerrilla de las Farc, tuvieron la posibilidad de sustituir un cultivo para uso ilegal por el de cacao, sin duda uno que les trajo un mejor sabor de boca, más dulce y que, igual que cuando se sorbe el último trago de chocolate, los llena de tranquilidad.
En estas zonas el promedio de edad de los cacaocultores es de 60 años en adelante, lo que significa que hay que hacer mucho énfasis en la inclusión generacional para que este cultivo no se pierda porque es ancestral”.
Luz Marina Correa Zabala, consultora del proyecto.
“EAFIT nos brindó un apoyo significativo en el proyecto Efecto Cacao. En este tiempo nos han apoyado en la elaboración de bases de datos, talleres de gestión documental y aprendizajes sobre la implementación de la página web, entre otros. Con estos apoyos hemos podido tener avances importantes en nuestra organización”.
“EAFIT ha despertado en nosotros ese componente social y ha hecho que jóvenes quieran pertenecer a nuestra organización, y que de esa forma ayuden en sus casas y en los campos a los cultivos. Ha sensibilizado a la juventud y vemos posible ese relevo generacional que necesitamos”.
Representante legal de Aspropisat (Tierradentro, Montelíbano, Córdoba)
“Uno de los logros más significativos es el empoderamiento a todos los integrantes de la junta directiva. Las capacitaciones nos han enriquecido mucho y hoy tenemos una capacidad instalada”.
Chocolate artesanal El abuelo Romero Tierradentro (Córdoba)
“Yo trabajo en la transformación del cacao y el chocolate de mesa. Siento que ahora tenemos una base económica familiar. Nos han apoyado mucho en finanzas y mercadeo”.

 Manuel Pérez Díaz Representante legal de la Asociación de Cacaoteros (San Pedro de Urabá)
Jorge Luiz Vergara
Marinella Prada Cortés Aprocalg (Algeciras, Huila)
Enember Romero
Manuel Pérez Díaz Representante legal de la Asociación de Cacaoteros (San Pedro de Urabá)
Jorge Luiz Vergara
Marinella Prada Cortés Aprocalg (Algeciras, Huila)
Enember Romero
Este laboratorio ha transformado los ambientes de aprendizaje de cientos de instituciones de educación básica y media en el país. En la actualidad, es un soporte del Ministerio de Educación, con el que sigue desarrollando avances por un aprendizaje más acorde con el mundo contemporáneo.
Por Pompilio Peña, colaboradorLa pandemia de la covid-19 afectó duramente las actividades académicas del país. Los expertos más optimistas apuntaron a que las brechas que causó podrían cubrirse en cinco años. No obstante, Diego Leal Fonseca, director adjunto del Centro Imaginar Futuros de la Universidad EAFIT y experto en innovación educativa, estima que los efectos de ese aislamiento obligatorio se notarán, incluso, hasta el 2030.
Pero hay una mirada optimista. Los retos, exigencias y planes de acción implementados durante la pandemia, para fortalecer el ya deteriorado sistema educativo, abrieron una nueva puerta a expertos para analizar cómo era posible vigorizar el Ecosistema Nacional de Innovación Educativa.
Uno de ellos fue Leal, quien viene aportando al mejoramiento de este tema, tanto en ámbitos regionales como nacionales, junto con su equipo del Centro Imaginar Futuros, un laboratorio que tiene como propósito fortalecer las capacidades de los diferentes actores que conforman el ecosistema educativo nacional.
Pero ¿qué entender por ecosistema educativo? Según Leal, “cuando nosotros pensamos en un ecosistema de innovación educativa, estamos pensando en esa perspectiva biológica que habla de actores, relaciones, conexiones, y cómo se pueden dar nuevas posibilidades para reimaginar lo que se hace, aplicando la innovación educativa, que no solo pasa por el mejoramiento tecnológico”.
Bajo esa perspectiva, uno de los grandes retos es lograr una articulación entre distintos niveles educativos, con el fin de entender cuáles son las realidades y dificultades de los estudiantes y cómo pueden superarse, más aún en tiempo de pospandemia.
Esta mirada holística propuesta por el Centro Imaginar Futuros, que pretende superar un viejo modelo educativo que está al margen de las exigencias de la actualidad mundial, lleva más de una década de aplicación. Una de sus primeras intervenciones fue en el municipio de Itagüí y los efectos positivos de su mediación aún repercuten.
Con el inicio de la gestión de Carlos Andrés Trujillo en 2012 como alcalde del municipio de Itagüí, la nueva administración comenzó a cuestionar el modelo tradicional de educación y se dio a la tarea de buscar asesorías que le permitiera implementar nuevos procesos de aprendizaje.
“En ese orden de ideas tuvimos una asesoría inicial de la exministra de Educación Cecilia María Vélez, quien nos recomendó, además, que enlazáramos la conversación con la Universidad EAFIT”, recordó el secretario de Educación, Guillermo León Restrepo.
En aquel entonces, el estudio de las condiciones educativas de ese municipio del sur del área metropolitana fue liderado por Claudia María Zea, experta en temas de innovación educativa, aprendizaje digital y colaborativo, formación de docentes y producción de contenidos digitales.
Zea y su equipo realizaron un diagnóstico del sistema educativo para luego desarrollar, de manera específica, un plan de tecnologías aplicadas a las aulas escolares en 24 instituciones educativas, con 38 sedes, 580 aulas y 1.300 directivos y docentes.

Fue así como nació el Plan Digital Teso, que hoy lleva el nombre de Plan Digital Itagüí. Esa intervención se estructuró en cuatro ejes temáticos: evaluación de la infraestructura tecnológica; replanteamiento de los procesos de formación de aprendizaje de estudiantes, maestros y funcionarios; desarrollo de una estrategia de gestión de innovación, desarrollo e investigación; y aplicación de indicadores de gestión de las tres líneas ya citadas.
De este modo, se trazó una visión al 2023 en su Plan Educativo Municipal, que refleja el proceso evolutivo iniciado en 2012. Esa estrategia se tradujo en inversiones en ambientes de aprendizaje, mayor conectividad y sinergia entre los diferentes actores, y los estudiantes se convirtieron en el capital más importante.
La experiencia lograda en Itagüí llevó a los expertos de EAFIT a dar un salto cualitativo en sus pretensiones pedagógicas. Se pasó, según Leal, de instruir a unos pocos docentes entusiastas a desarrollar espacios de formación para cientos de maestros, directivos y funcionarios.
“Ya no estábamos hablando de trabajar solamente con unos cuantos docentes. Ahora pensábamos que queríamos despertar ciertas capacidades en el profesor para convertirlo en promotor y gestor de la innovación educativa; y nos preguntamos cuáles eran las capacidades a desarrollar en un directivo-docente, con el fin de que este pudiera entender qué está pasando en las aulas”, recordó el experto.
Y agregó que este ejemplo expone la mirada integral y ecosistémica, en el que los roles se reconfiguran y los estudiantes ya no se conciben como actores pasivos en su proceso, sino como personas que pueden contribuir a la vida de su institución educativa.
Luego de esta intervención local, el equipo de trabajo de innovación educativa de la EAFIT tuvo la oportunidad de escalar su experiencia en 2015. De la mano del Ministerio de Educación, logró intervenir en 200 instituciones educativas de diversas regiones del país.

Al año siguiente, la Secretaría de Educación de Bogotá solicitó sus servicios para desplegar una estrategia, similar a la de Itagüí, en 383 instituciones educativas de la capital de la República.
Mejorar los entornos escolares y dotarlos de tecnología son logros tangibles de este enfoque basado en la innovación.
Cuando nosotros pensamos en un ecosistema de innovación educativa, estamos pensando en esa perspectiva biológica que habla de actores, relaciones, conexiones, y cómo se pueden dar nuevas posibilidades para reimaginar lo que se hace".
Diego Leal Fonseca, director adjunto del Centro Imaginar Futuros de la Universidad EAFIT.
“Hicimos, por un lado, un ejercicio de desarrollo de capacidades entre profesores, fortalecimos las redes autónomas de estudio y el trabajo entre la Secretaría y los docentes. Meses después, nos encontramos con que esta lógica de ecosistema fue importante para darle la vuelta a un relato de escepticismo sobre nuestro trabajo”, aseguró Leal.
En los últimos años, el Centro Imaginar Futuros, de la mano de la subdirección de Fortalecimiento Territorial del Ministerio de Educación, hizo un acompañamiento técnico de apoyo a todas las secretarías de Educación del país en la formulación e implementación de sus Planes de Innovación Educativa Territorial. El modelo ecosistémico cobró entonces una lógica nacional, enfocado en la educación básica y media.
De allí nació, en 2019, el proyecto Co-Lab, el Laboratorio de Innovación Educativa para la Educación Superior, adscrito al Ministerio de Educación, y del cual Leal y su equipo hicieron parte. En su sitio web se encuentran referentes, buenas prácticas, diálogos sobre las posibilidades y retos del sector, recursos digitales abiertos y acciones de acompañamiento entre pares.

A este avance se sumó otro proyecto: el Observatorio de Trayectorias Educativas, liderado por el Ministerio de Educación y que tiene como objetivo promover estrategias que potencien la trayectoria de los estudiantes, gracias a información suministrada por amplias bases de datos que recogen sus vidas académicas.
Al reflexionar sobre todas esas experiencias, Leal consideró que la actualidad imprime nuevas velocidades, cambios y retos en la educación, que se están estudiando en Imaginar Futuros. Entre los retos encontrados, se estableció que se deben seguir mejorando los resultados de aprendizaje en todos los niveles, un asunto que conecta con los efectos de la pandemia.
“También cabe pensar en la configuración que se está dando en el mundo con la llegada de la economía digital, por lo que deben fortalecerse los conocimientos de los estudiantes en este ámbito, a la vez que se comienza a dejar a tras un viejo paradigma educativo, por uno más integral y abierto a las posibilidades que ofrecen las tecnologías”, razonó este experto.
Durante cuatro años, cerca de 300 investigadoras e investigadores se integraron a esta alianza para hacer realidad el sueño de ofrecer alternativas viables de transición energética en un mundo agobiado por los efectos del cambio climático. Y no quieren parar, pues el reto es inmenso y las soluciones no dan espera.

Ataviado con su vestimenta tradicional, Asdrubal Torres, líder indígena del pueblo arhuaco, llegó al Auditorio Fundadores de la Universidad EAFIT en busca de conocimientos y contactos sobre nuevas maneras de producir energía para la comunidad de Nabusimake, asentada en la cara oriental de la Sierra Nevada de Santa Marta.
Era la mañana del 30 noviembre de 2022 y en el Fundadores se concentraban investigadoras e investigadores de diferentes ciencias aplicadas que tenían un interés común: la transición energética, un tema sobre el cual Torres tenía grandes expectativas.
Todos estaban en aquel auditorio porque ese día, y los dos siguientes, se realizaría el Encuentro Nacional Energética 2030, un evento en el que se presentaban los resultados de cuatro años de investigación interinstitucional y de concreción de proyectos que le apuntan a ofrecer soluciones para enfrentar los efectos del cambio climático.

Definida como “la iniciativa científica más grande de la historia de la ciencia” en el país, Energética 2030 recibió en mayo de 2018 apoyo de Colciencias (hoy Ministerio de Ciencia, Tecnología e Innovación), y partir de allí se constituyó un equipo de 300 investigadoras e investigadores de ocho universidades colombianas, cuatro empresas del sector eléctrico nacional y 12 centros de educación superior del exterior.
Esta alianza concibió once proyectos de alto impacto enfocados en la transición energética, invirtiendo en ello cerca de 37 mil millones de pesos, de los cuales el Gobierno nacional, a través de Minciencias, aportó por lo menos 18 mil millones de pesos.
Por eso Torres estaba en aquel auditorio, tenía claro que allí podría encontrar los contactos pertinentes que le ayudaran a pensar y aplicar un proyecto de energía solar que beneficiara a los pobladores de Nabusimake, considerada la ciudad sagrada del pueblo arhuaco.
“Me interesa muchísimo hacer una alianza con la comunidad y poder capacitarnos, desarrollarnos, sabemos que todo se basa en la educación y la información. Una cosa es querer, pero detrás de todo eso hay que aprender las cosas”, afirmó Torres.
Sus palabras fueron escuchadas por Camilo Younes, vicerrector de investigación de la Universidad Nacional de Colombia en su sede de Manizales, quien minutos antes de encontrarse con Torres había afirmado en su intervención en el primer foro del evento que “Energética 2030 es ciencia para la ciudadanía”.
Jóvenes participantes de proyectos promovidos por la alianza Energética 2030.
En la conversación con el líder indígena, Younes amplió esa apreciación: “Toda la ciencia tiene que ser ciencia para la ciudadanía porque los procesos de transición energética son para y con la ciudadanía, si no, no funcionan. Se puede hacer el mejor desarrollo tecnológico, pensar los mejores métodos o herramientas o tecnologías de transición energética, pero ¿quién las usa?”.
Serena, una lancha que funciona con energía solar, resultado del proyecto Movilidad Eléctrica.
El vicerrector Younes dirige el Laboratorio de Co-creación, uno de los 11 proyectos que hace parte de Energética 2030. En su diálogo con Torres, reiteró que la transición energética no es un fin, “es un medio para generar bienestar en las comunidades”.
¿Y ese enfoque cómo se articula con inquietudes como las planteadas por el líder arhuaco? Al respecto, Younes planteó una ruta de trabajo: “Lo primero que hay que hacer es ir a hablar con el pueblo Arhuaco. Nosotros no tenemos que ir a decirles cómo tienen que hacer las cosas, porque ellos tienen mucho que enseñarnos. Entonces, a partir de ahí, generamos estrategias que sean respetuosas con los saberes ancestrales y que generen bienestar a la comunidad, pero se tienen que apropiar y eso solo se hace con la comunidad”.
En las entrelíneas de ese diálogo entre Torres y Younes subyace un aspecto que marcó las dinámicas de trabajo alrededor de Energética 2030: la colaboración. Así lo destaca Santiago Ortega, investigador de la Universidad EIA y director del proyecto Análisis de escenarios y definición de estrategias futuras
“El balance más importante y más fuerte de Energética 2030 es el tema de la colaboración. Nosotros trabajábamos muy en nicho, a veces colaborábamos los unos con los otros, pero nunca tuvimos un proceso de colaboración a tan gran escala, tan potente y tan armónico desde el principio”, planteó el académico.

Y recordó lo que ocurrió hace cinco años, cuando se estaba empezando a diseñar y formular este proyecto: hubo un clic entre todos aquellos que confluyeron en esa iniciativa, se evidenció que los investigadores empujaban para el mismo lado y se concluyó que en vez de competir era necesario cooperar.
“Cuatro años después se recogen los frutos de esa cooperación, de ese trabajo conjunto, de esa confianza tan grande construida entre todos. Este ecosistema, académicamente, nos cambió la vida a muchos investigadores”, aseveró Ortega.
En esa apreciación coincidió José Ignacio Marulanda, docente de la Universidad EAFIT y director del proyecto Construcción Sostenible
A su juicio, Energética 2030 es más que un conjunto de proyectos: “Es el escenario de una verdadera alianza donde nos conocimos una cantidad de actores. Somos investigadores muy atomizados y en esta alianza había apoyo por todos lados, colaboraciones y sinergias”.

Y no fue fácil lograr lo que los investigadores Ortega y Marulanda destacan. Las labores propuestas se vieron afectadas por el avance de la pandemia generada por la covid-19. En el segundo año de actividades se cerraron los laboratorios, se dificultaron las importaciones de insumos y se encarecieron los procesos. Pero el trabajo no se detuvo. “Nos dedicamos a lo que podíamos hacer en pandemia: diseños, documentación”, recordó Marulanda.
El fortalecimiento de la colaboración y la superación de obstáculos genera una reflexión sobre el papel del Estado en la búsqueda de nuevas opciones de transición y eficiencia energética. A juicio de este investigador, es “necesario integrar fuerzas y apuntar para el mismo lado”.
La pregunta es: ¿cómo vamos a seguir? Todo avanza rápidamente, hemos vivido cambios importantes, eso va a seguir sucediendo y tenemos que estar preparados para todo lo que viene".
María Noemí Arboleda, gerente general de XM.
La transición energética está en la agenda del actual Gobierno nacional y más allá de las polémicas que suscita, la integración con la universidad y la empresa es esencial para “no estar a tientas y tomar decisiones apresuradas”, planteó Marulanda.
Después de cuatro años de arduo trabajo, esta iniciativa interinstitucional ahora busca futuro con la experiencia alcanzada. Para Marulanda, el horizonte es promisorio, siempre y cuando “empecemos desde ahora”.
Y uno de esos horizontes más inmediatos es el nuevo plan nacional de desarrollo, actualmente en discusión en el Congreso de la República. De acuerdo con Sergio Cristancho, viceministro de Conocimiento, Innovación y Productividad, esta alianza aporta elementos para ese debate en dos sentidos: “Por un lado, los avances logrados en materia de transformación energética por un ecosistema como Energética 2030 se constituyen en un insumo fundamental para la hoja de ruta que se está elaborando por parte del Ministerio de Minas y Energía para la transición energética del país”.
A su juicio, la idea con los desarrollos que surgieron a partir de investigaciones realizadas durante estos cuatro años es que comiencen a tener aplicaciones concretas, “sobre todo desde la transición energética justa y a mirar cómo esas adaptaciones tecnológicas se pueden hacer para que impacten comunidades tradicionalmente con inequidades y que puedan generar alternativas de desarrollo económico y social”.

Y de otro lado, según el funcionario, también aporta desde el punto de vista de la metodología: “La metodología de ecosistemas demuestra con este tipo de resultados ser muy buena para lograr la articulación de universidad, empresa, Estado y sociedad, de cara a resolver otros desafíos más allá de la transición energética”.
María Noemí Arboleda, gerente general de la firma XM, operadora del Sistema Interconectado y administradora del mercado de energía mayorista del país, celebró los resultados logrados: “Es una contribución demasiado importante para la industria”, aseguró en el foro Colombia hacia la transición energética: ruta, capacidades, avances y retos, que abrió la presentación del balance de esta alianza interinstitucional.
Esta filial del holding estatal Interconexión Eléctrica S.A. (ISA) es una de las cuatro empresas aliadas de Energética 2030. Su participación fue clave en por lo menos cuatro de los proyectos desarrollados por esta alianza Arboleda reconoció que aún falta camino por recorrer en la transición energética del país, pero insistió en la importancia de lo realizado, sobre todo en la formulación de proyectos y formación de nuevos investigadores: “Pero no es para quedarnos ahí. La pregunta es: ¿cómo vamos a seguir? Todo avanza rápidamente, hemos vivido cambios importantes, eso va a seguir sucediendo y tenemos que estar preparados para todo lo que viene".
Con respecto a la sostenibilidad, el viceministro Cristancho aseguró que muy probablemente en este gobierno salgan convocatorias públicas, abiertas y competitivas, que son mecanismos de los cuales dispone el Ministerio de Ciencia, Tecnología e Innovación para financiar este tipo de proyectos.
Para Jairo Espinosa Oviedo, director científico de Energética 2030, el esfuerzo de concentrar a 300 investigadoras e investigadores implicó una tarea de confianza entre todos y generó la capacidad de soñar: “Para aunar las voluntades es fundamental que los retos sean grandes y el de la transición energética para atender el reto climático es inmenso. Justo eso hizo que todos comenzáramos a pensar en grande”.
El progreso alcanzado en estos cuatro años se ha convertido en el motor para llegar con soluciones concretas no solo al 2030, como se lo propuso esta alianza, sino al 2050, año en el que se prevé que concluya la transición energética en el mundo.
La continuidad de Energética 2030 está ligada a políticas de Estado, asunto que el director científico lo considera fundamental: “Esta es una iniciativa que comienza en el gobierno Santos, continua en el de Duque y lo estamos cerrando en el gobierno Petro. Si pensamos en completar esa transición a 2050, estamos hablando de 28 años y siete gobiernos. Es por ello que aquí es importante la coherencia como Estado y que se planteen recursos que permitan generar esa continuidad”.

Espinosa agregó que el momento es importante porque “estamos involucrados en una sociedad que necesita un cambio y que está mirando hacia la ciencia como la generadora de respuestas”.
Ver video
Energética 2030: Resultados del proyecto de Movilidad Sostenible.
 El Encuentro Nacional Energética 2030 contó con la participación de de representantes del Estado, la academia, la industria y la sociedad civil.
El Encuentro Nacional Energética 2030 contó con la participación de de representantes del Estado, la academia, la industria y la sociedad civil.
Retos
transición
en Colombia a través de la apropiación social del conocimiento. Ecosistema Científico Energética 2030 como un ejemplo a seguir.
Por Camilo Younes, Vicerrector de Investigación, Universidad Nacional de Colombia

La Organización de las Naciones Unidas adoptó, desde el encuentro de las partes en Rio de Janeiro en 1991, la definición de desarrollo sostenible como “la satisfacción de las necesidades de la generación presente sin comprometer la capacidad de las generaciones futuras para satisfacer sus propias necesidades”.1
Dentro de los retos más grandes que tiene la humanidad en el marco del desarrollo sostenible está sin duda la necesidad de garantizar los recursos energéticos para la presente y las futuras generaciones.
A pesar de ingentes esfuerzos, particularmente en las últimas tres décadas, aún la dependencia energética basada en recursos fósiles sigue siendo muy alta, según el más reciente informe de la Agencia Internacional de Energía (IEA por sus siglas en inglés), casi el 80% del suministro de energía a nivel mundial está basado en estos recursos.
y desafíos de la
energética justa
La justicia es un dispositivo convencional para preservar el orden social mediante la solución de disputas entre individuos que están haciendo incompatible sus reclamos…sobre recursos escasos".
David Hume.
Adicionalmente, los efectos del conflicto entre Rusia y Ucrania han mostrado que posiblemente sean los recursos energéticos los detonantes de los futuros conflictos a nivel mundial y que la seguridad y soberanía energéticas jugará un papel fundamental en el desarrollo de las naciones. Esto sin contar con los ajustes que en materia de geopolítica y relacionamiento internacional se están viviendo, especialmente en materia financiera, que han generado nuevas tensiones entre modelos económicos basados en enfoques financistas y bursátiles globalistas por un lado y modelos con mayor énfasis en el uso de los recursos naturales como elemento de negociación regional por el otro.
Teniendo en cuenta la necesidad de profundizar los procesos de descarbonización frente a las realidades de la catástrofe climática que se aproxima por los efectos antropogénicos relacionados con el cambio y la variabilidad climática, la transición energética debe seguir estando en la agenda mundial, pero especialmente en la nacional.
Una transición energética responsable, especialmente en países en como Colombia, debe ser diseñada adecuadamente, de tal forma que no se ponga en riesgo la posibilidad real y efectiva de que la nación se vea beneficiada, pero con un horizonte de responsabilidad planetaria pensando en las futuras generaciones.
Lo anterior implica enmarcar los procesos de transición energética bajo la luz de la justicia energética, entendida como como la agenda de investigación y análisis que busca aplicar los principios de justicia a la política energética, a los sistemas y producción de energía, al consumo energético, al activismo energético, a la seguridad y soberanía energéticas, a la política económica de la energía y especialmente al cambio climático.2
Hablar de justicia energética demanda un análisis en al menos tres dimensiones: justicia distributiva, justicia del reconocimiento y justicia procedimental.
La justicia distributiva aborda las problemáticas asociadas con las inequidades físicas de la ubicación de los grandes centros de generación de energía, que generalmente afectan a ciertos sectores de la población dónde se hacen las instalaciones. Tiene que ver con la distribución de daños y beneficios entre la población.
Hay cierta aceptación generalizada en el sentido de que siempre habrá impacto y que alguien debe verse afectado de manera individual para que otros obtengan los beneficios del desarrollo, o, en otras palabras, el interés general prima sobre el individual. Sin embargo, usualmente son los sectores más desfavorecidos los que terminan soportando las cargas de los procesos e instalación de nuevos desarrollos energéticos, v.g. la construcción de una gran hidroeléctrica que afecta a las poblaciones río abajo por el impacto ambiental, el deterioro en la pesca, la carga de biomasa y generación de residuos para sus acueductos, entre otros. Adicionalmente, la justicia distributiva no solamente trata de la ubicación de la infraestructura, sino del acceso equitativo al recurso energético, no son pocas las veces que las poblaciones que soportan el mayor impacto de un nuevo megaproyecto energético sean las que menos acceso tienen a dicho recurso.
1 Brundtland, G. (1987). Informe: Nuestro futuro común. Comisión Mundial sobre Medio Ambiente y Desarrollo.
2 Jenkins, K., McCauley, D., Heffron, R., Stephan, H., & Rehner, R. (2016). Energy justice: A conceptual review Energy Research & Social Science, 11, 174-182.
La justicia del reconocimiento aborda la necesidad de incorporar, en las decisiones de carácter energético, las particularidades y contextos que caracterizan la diversidad social, cultural y étnica de las poblaciones afectadas por los procesos asociados. No es solo la falta de reconocimiento, sino que con frecuencia hay un absoluto desentendimiento de estas características de las poblaciones. Los procesos tienden a ser homogeneizantes y detrás de una fachada de igualdad, terminan siendo victimizantes para las poblaciones que se ven más afectadas por los proyectos de carácter energético. Países como Colombia, que cuentan con contextos culturales, étnicos y sociales altamente diversos, con realidades y brechas económicas muy grandes, deja en cabeza de las minorías más desfavorecidas las mayores cargas derivadas de los proyectos energéticos. Un mínimo reconocimiento de sus realidades y contextos en el marco de los procesos de desarrollo es un deber ético del Estado colombiano.
Finalmente, la justicia procedimental está relacionada con acciones efectivas de involucramiento de las comunidades en los procesos de toma de decisión que gobiernan el reconocimiento de dichos sectores descritos anteriormente.
Demanda generar procesos equitativos de vinculación de todos los actores de manera no discriminatoria a través de sistemas legales
multinivel. Esta dimensión de la justicia energética implica adicionalmente involucrar diálogo de saberes y movilizar saberes locales en los procesos de toma de decisión. Más que buscar no excluir a las comunidades, implica escuchar e implementar sus conocimientos en los territorios donde se busca generar proyectos de carácter energético.
Con el fin de pensar los procesos de transición energética en Colombia y su estrecha relación con la Agenda 2030 de la Organización de las Naciones Unidas, en el año 2017 se aprobó por parte de Colciencias3 el Programa Estrategia de transformación del sector energético


Los efectos del conflicto entre Rusia y Ucrania han mostrado que posiblemente sean los recursos energéticos los detonantes de los futuros conflictos a nivel mundial”.
colombiano en el horizonte 2030 – Energética 20304 por un valor total de $37 mil millones de pesos.
Este Programa hace parte de una estrategia de ecosistemas científicos para el mejoramiento de la calidad de las Instituciones de Educación Superior (IES), del cual hacen parte 8 universidades colombianas, 12 instituciones internacionales, más de 300 investigadores y 5 empresas.
El Ecosistema está compuesto por 11 proyectos que abordan diferentes temáticas relacionadas con los procesos de transición energética con aspectos como nuevas tecnologías de fuentes renovables de generación de electricidad, gestión de la demanda de energía, estrategias futuras, movilidad y construcción sostenible, política y regulación energética, entre otras.
El proyecto 10 de Energética 2030 estuvo enfocado a los procesos descritos inicialmente de justicia y transición energéticas mediante la implementación de un laboratorio de co-creación y apropiación social de la Ciencia, Tecnología e Innovación, que involucre a la comunidad, la academia, el sector productivo y el sector gubernamental.
El Laboratorio fue implementado en Isla Fuerte5 con los sectores descritos anteriormente, donde la comunidad tuvo un papel protagónico y derivado del mismo se lograron

La ejecución de proyectos locales y regionales necesita incorporar, en las decisiones de carácter energético, las particularidades y contextos que caracterizan la diversidad social, cultural y étnica de las poblaciones beneficiadas. Foto: Cortesía Proyecto Laboratorio de Co-Creación.
establecer cuatro proyectos productivos y sociales que se espera que generen oportunidades y bienestar a la población a través del uso de fuentes renovables de generación de energía eléctrica.
Los procesos de transición energética deben estar enmarcados en conceptos de justicia energética, esto implica reconocer a las comunidades, especialmente las más vulnerables como actores claves, así como sus saberes, para lograr que, a través de procesos de co-construcción, se puedan apropiar adecuadamente de los desarrollos de la ciencia para la generación de bienestar con una mirada de desarrollo basado en la sostenibilidad.
Este fue el propósito del Ecosistema Científico Energética 2030 y especialmente del equipo interdisciplinario del proyecto P10, gracias a un esfuerzo acertado del Estado colombiano que debe continuar para apoyar a la consolidación real de una sociedad basada en el conocimiento pero que respete la diversidad, los saberes y los contextos de las comunidades involucradas.
3 Departamento Administrativo de Ciencia, Tecnología e Innovación. Fue transformado en el Ministerio de Ciencia, Tecnología e Innovación de Colombia.
4 https://www.energetica2030.co/
5 Isla Fuerte es un corregimiento del Distrito Turístico de Cartagena de Indias en Colombia y hace parte de su sistema insular. Está ubicada frente a las costas del Departamento de Córdoba al sur del Golfo de Morrosquillo.
El Premio Anual de Investigación 2022 reconoció la trayectoria y las labores de cinco docentes investigadores, cuyas contribuciones trascienden la académica e impactan a la sociedad.
Por Felipe Sossa, colaboradorDedicar la vida a la búsqueda de nuevos conocimientos, y que esos resultados tengan un impacto positivo en la sociedad, que sean una respuesta o solución a algo específico de las comunidades, es la continua motivación de un científico. Y para ayudar a que ese deseo de investigar se mantenga vigente, la Universidad EAFIT otorga cada año el Premio Anual de Investigación con el propósito de reconocer a sus docentes, grupos o proyectos con resultados destacados.
En 2022, en ceremonia celebrada el 16 de mayo en el marco de la celebración del Día del Profesor, la Universidad exaltó la labor de varios investigadores que, con sus labores a favor de la ciencia y la academia, han alcanzado aportes significativos para el ámbito universitario y de gran trascendencia social.

El término ‘científico’ se deriva del latín scientificus (scientia –conocimiento– y fic, de facis, –hacer–). Y para estimular a quienes hacen conocimiento, en 2012 fue establecido el Premio Anual de Descubrimiento y Creación Universidad EAFIT, el cual cumplió ya una década y ha premiado a decenas de sus investigadores.
Este premio lo entrega cada año el Consejo Directivo de la Universidad y representa un reconocimiento público y económico que motiva la consolidación de la comunidad científica eafitense. El galardón se otorga en dos categorías:
1. Trayectoria de investigación: exalta a un profesor y científico por su desarrollo de proyectos y actividades con aportes significativos a su campo de estudio.
2. Investigación de mayor impacto: se reconoce la labor con un aportes significativos en innovación, impacto social, científico y tecnológico.
En la ceremonia de entrega de los premios en su versión de 2022, la rectora Claudia Restrepo Montoya resaltó el significado que tiene entregar estos reconocimientos en mayo, pues fue justo en este mes que se fundó la Universidad, justo hace 63 años: “El mes de mayo nos conecta con muchas cosas: primero, tuvimos la oportunidad de celebrar lo que somos; y ahora estamos acá, reunidos, celebrando a todos aquellos que hacen posible la Universidad, la esencia de EAFIT”.
Además de entregar el Premio Anual de Investigación, en ese encuentro de la comunidad universitaria se otorgaron tres más: Excelencia Docente, Proyección Social y Promoción de la Interculturalidad y Bilingüismo.
Cinco profesores fueron exaltados con el Premio Anual de Investigación 2022. Ellos fueron:
• Categoría: Trayectoria de Investigación
Diego Fernando Villanueva Mejía Escuela de Ciencias Aplicadas e Ingeniería
Mención especial
Jonny Javier Orejuela Gómez Escuela de Artes y Humanidades
• Categoría: Proyecto de mayor impacto
John Jairo García Rendón Escuela de Finanzas, Economía y Gobierno.
Menciones especiales
Alex Armando Sáez Vega Escuela de Ciencias Aplicadas e Ingeniería
Mónica Lucía Álvarez Laínez Escuela de Ciencias Aplicadas e Ingeniería
Reconocimiento especial
Luciano Ángel Toro Escuela de Ciencias Aplicadas e Ingeniería
Ver video
Premio Anual de Investigación 2022, categoría trayectoria de investigación.
Ver video

Premio Anual de Investigación 2022, categoría Proyecto de mayor impacto.

Diego Fernando Villanueva Mejía recibió el reconocimiento en la categoría Trayectoria de Investigación del Premio Anual de Investigación EAFIT. “Fue algo supremamente gratificante, me sentí el hombre más feliz de la vida”, dice el profesor, quien reconoce que lloró el día de la premiación porque se emocionó al sentir que valoraban su vida dedicada a la ciencia.
Nació en 1981 en la ciudad de Ibagué, capital del departamento de Tolima, y es egresado de Biología de la Universidad del Tolima. A Medellín llegó en 2002 a realizar su tesis de grado con la Corporación para las Investigaciones Biológicas (CIB) y laboró allí hasta 2012, cuando luego de algunos años como docente de cátedra y de liderar como contratista la creación del pregrado en Biología en EAFIT, se unió como docente e investigador de planta. Es magíster y doctorado en Biotecnología.
Su experiencia se enfoca, principalmente, en el mejoramiento genético de plantas y microorganismos con técnicas de biotecnología moderna como la ingeniería genética y la edición genómica.
El Premio Anual de Investigación, categoría Proyecto de mayor impacto, fue para el profesor John Jairo García Rendón, como líder de Política, Regulación y Mercados, uno de los diez proyectos que conforman Energética 2030, una estrategia de transformación productiva del sector energético en Colombia que agrupa a varias universidades y centros de investigación del país y del extranjero.

“Ya nos propusimos un objetivo: diseñar los mecanismos institucionales para dar cabida a las energías renovables no convencionales y redes inteligentes en general en el mercado eléctrico nacional”, explica el profesor García.
El equipo de Política, Regulación y Mercados generó conocimiento con seis artículos en revistas científicas internacionales; además, aporta experiencia y conocimiento en la formación de estudiantes de pregrado y posgrado; y contribuye a fortalecer la interacción entre Universidad y Empresa.
En este proyecto trabajan de manera mancomunada junto a EAFIT, cuatro universidades –Duke University, AARHUS University, Universidad Nacional Sede Medellín y Universidad Pontificia Bolivariana–; y dos operadores del mercado eléctrico colombiano –XM S.A. e Interconexión Eléctrica S.A.–.
El investigador Jonny Javier Orejuela Gómez, de la Escuela de Artes y Humanidades, recibió una mención de honor en la categoría Trayectoria de investigación. Este científico es doctor en Psicología Social del Trabajo de la Universidad de São Paulo (Brasil) y Es un apasionado por la investigación en psicología y las ciencias sociales. Y reconoce que es un apasionado por la investigación en Psicología y las Ciencias Sociales.
Asimismo, Alex Armando Sáez Vega y Mónica Lucía Álvarez Laínez, adscritos a la Escuela de Ciencias Aplicadas e Ingeniería, recibieron mención de honor en Proyecto de mayor impacto.
Sáez Vega, Doctor en Ciencias Químicas de la Universidad de Antioquia, ha profundizado en la captura a partir de microalgas de dióxido de carbono (CO2), uno de los principales gases que produce el llamado efecto invernadero, contribuyendo así al calentamiento global. Sobre la mención recibida, expresa que “el significado más importante es el respaldo de EAFIT. Sentí un espaldarazo fuerte, un apoyo al trabajo que he estado haciendo. Ese es el contexto más significativo: el respaldo de una gran institución”.

La profesora Mónica Lucía Álvarez, por su parte, ha investigado sobre el valor agregado y alternativas de aprovechamiento del látex de caucho natural del Bajo Cauca antioqueño. Igualmente, su profundización en la nanotecnología ha sido trascendental en proyectos como el escalado de nanofibras poliméricas para aplicaciones en sistemas de protección respiratoria, el cual obtuvo como resultado una membrana con una capacidad de filtración superior al 98%, muy valorada en el sector salud para fabricar elementos como tapabocas.
Finalmente, Luciano Ángel Toro fue distinguido con un reconocimiento especial por sus investigaciones en física y su compromiso académico y docente durante más de 30 años.
Este premio es consecuencia de muchísimos años de trabajo, de sacrificar grandes momentos con mi familia. Estoy muy feliz con lo que he hecho y con seguridad lo seguiré haciendo”.
Diego Fernando Villanueva Mejía. Premiado en la categoría Trayectoria de Investigación.
Esta estrategia de intervención, que ha desarrollado diversas acciones en lugares públicos, pretende motivar conversaciones amplias sobre temas complejos para la sociedad como la guerra y la paz. Sus resultados animan a sus promotores a continuar abriendo nuevos espacios de diálogo.
El semillero de Psicología y Ciencia Política de la Universidad EAFIT, a través de su estrategia Saber para Sanar, busca con múltiples iniciativas de apropiación social aportar a la construcción de paz en el país. Combinando saberes y metodologías colaborativas, ha logrado construir espacios seguros de diálogo y reflexión sobre el impacto de la guerra en la sociedad colombiana, propiciando conversaciones incómodas sobre temas que pocas veces nos atrevemos a abordar.

A mediados del año pasado, este semillero inició una serie de actividades de interacción con públicos diversos, tanto de la comunidad universitaria, como con otras personas interesadas en su propuesta. No obstante, el lanzamiento del informe final de la Comisión para el Esclarecimiento de la Verdad (CEV) a finales de junio del año pasado, que explica lo ocurrido durante 50 años de guerra, se convirtió en la oportunidad para abrir el diálogo que venían teniendo internamente e integrar a otras personas para abordar, desde un enfoque psicológico, los efectos que ha dejado la violencia en nuestra sociedad, y así, empezar a sanar las heridas.
 Por Vanessa Reyes Restrepo, colaboradora
Por Vanessa Reyes Restrepo, colaboradora
El semillero nació en 2015 por iniciativa de la profesora Marda Eucaris Zuluaga, quien atrajo el interés de algunos estudiantes del pregrado en Psicología para reunirse y explorar temas relacionados con el arte en su profesión. Posteriormente, producto de su trabajo de grado de doctorado, se conectó con temas ligados a la memoria y el conflicto, y decidió proponer un cambio de enfoque en el semillero.
Fue así como en el 2019 iniciaron reflexiones e investigaciones sobre psicología social y política. Para la docente, el arte siguió presente en sus actividades, pues, tal como ella lo resalta, “es una de las muchas manifestaciones expresivas a través de las cuales los seres humanos se pronuncian políticamente”.
Ese mismo año, varios de sus integrantes participaron en la Cátedra Colombiana de Psicología Mercedes Rodrigo, espacio virtual que reunió a estudiantes, investigadores y docentes universitarios de diversas regiones del país. En esa oportunidad, el encuentro académico

abordó el tema de reconstrucción de subjetividades e identidades en contexto de guerra y posguerra.
Esa experiencia les permitió acercarse a diversidad de trabajos y enfoques psicológicos como el de la institucionalización de la guerra, que despertó un interés especial en el semillero y los llevó a iniciar su primera investigación en la que analizaron actitudes y creencias sobre la paz y la guerra en Colombia a partir de las interacciones en los foros de Facebook de El Colombiano y El Espectador en cinco noticias publicadas por estos diarios relacionadas con el proceso de paz.
Actualmente, se encuentran en el proceso de escritura de los hallazgos de esa investigación, que posteriormente publicarán, pero que, desde ya, les deja reflexiones que nutren las labores que llevan a cabo con distintas comunidades.
Las actividades que realiza el semillero cuentan con el apoyo de varias áreas de la Universidad y de algunas organizaciones de la ciudad, lo que les ha permitido ampliar la participación y el diálogo con varios sectores sociales, así como la diversificación de formatos y metodologías de apropiación social del conocimiento.
Ana María González, coordinadora de Cultura de la Apropiación del área de Apropiación Social del Conocimiento adscrita a la Vicerrectoría de Ciencia, Tecnología e Innovación, ha impulsado la conexión de experiencias dentro y fuera de la Universidad con el semillero. A ella le llamó la atención las formas como la profesora Zuluaga y los estudiantes vinculan los contextos sociales en la apropiación social de los conocimientos que aborda el semillero.
Para González lo más interesante de la creación colaborativa y colectiva de esta experiencia es “que les permitió afinar cosas metodológicas de la mediación, porque no solamente es en función de los temas… Le aporta al método la genuinidad de los problemas reales que tienen las personas”.
La primera alianza que realizó el semillero con la estrategia Saber para Sanar fue en mayo del 2022, cuando compartieron con la Universidad de los Niños un espacio en el evento Días de EAFIT. Allí compartieron una carpa y material didáctico para que el grupo realizara la actividad Tendedero de Verdades, diseñada para invitar a la comunidad universitaria y a los visitantes a pensar maneras conjuntas de cruzar lo personal y lo colectivo como aporte a la construcción de paz, a propósito del anuncio de la entrega del informe final de la CEV al país, programado para el 28 de junio de ese año.
La actividad consistió en dejar pequeños papeles con preguntas como ¿hay alguna verdad que te haya cambiado la vida? El propósito era motivar a los visitantes a leer y a escribir sus reflexiones para luego colgarlas en las cuerdas dispuestas en la carpa, y así poder ser leídas por otros asistentes.
El segundo evento de la estrategia Saber para Sanar fue el club de lectura que co-crearon con el profesor de la maestría en Estudios Humanísticos, Juan Pablo Pino Posada. En su primer ciclo, se reunieron en una de las salas de la Biblioteca Luis Echavarría Villegas a leer el capítulo testimonial de la CEV. Tuvo convocatoria abierta y contó con la participación de una veintena de personas quienes, durante cuatro meses, asistieron a la cita cada miércoles a las siete de la mañana para activar el diálogo y la reflexión.
“Surgieron un montón de cuestionamientos y también se generaron muchas emociones de la lectura, pues los testimonios que trabaja la Comisión de la Verdad son muy fuertes… Entonces fue muy duro, pero también ha sido un proceso muy bonito, es como sanar el trauma colectivo en colectivo, que es uno de los propósitos de Saber para Sanar”, detalla Luisa Martínez, integrante del semillero.
Para estar al tanto de las actividades del semillero de Psicología y Ciencia Política pueden seguir su cuenta en Instagram: psicologiasocialypoliticaeafit

Debido al éxito que tuvo esta actividad, decidieron continuar para el 2023 con estos encuentros. Para su segundo ciclo, están planeando la lectura de los otros capítulos del informe de la CEV.
Adicional a ello, el semillero adoptó Cuatro Ojos, estrategia de cine foro de la Universidad de los Niños con el fin de propiciar diálogos sobre la importancia de tener conversaciones incómodas. Para su primera edición, eligieron la película Encanto, dedicada a Colombia y que la productora Disney estrenó en noviembre de 2021, para reflexionar con los asistentes sobre las emociones y la conexión de estas con la política.
Amiga Date Cuenta fue la última actividad que realizó el semillero en 2022. Contaron con el apoyo de la red ciudadana Antirumores y se llevó a cabo en las instalaciones de la Corporación Región. Se trató de un taller en el que los asistentes, 25 en total, reflexionaron sobre estereotipos, creencias e ideologías a partir del análisis colectivo del dicho popular ‘El pobre es pobre porque quiere’.
“En el taller y el cine club que hicimos, nos dimos cuenta que las personas tienen mucho por decir, que las personas quieren hablar de muchas cosas que pueden ser incómodas. Nos
Martínez, integrante del semillero.sorprendió también que las personas contaban sus historias de vida, su relación con el conflicto armado, eran muy abiertos en esos temas y es que buscan esos espacios en los que se pueda hablar y conversar desde el respeto”, reflexiona Laura Correa, estudiante y coordinadora del semillero.
Actualmente, el semillero está integrado por ocho personas entre estudiantes activos, egresados y una estudiante de maestría, quienes esperan continuar activando el portafolio de estrategias que han construido alrededor de la estrategia Saber para Sanar.
Al respecto, la profesora Zuluaga, su creadora, asegura que es una gran motivación seguir ampliando el semillero por una razón fundamental que ella expresa con claridad: “La paz la construimos entre todos, todos los días, con acciones pequeñas”.
Surgieron un montón de cuestionamientos y también se generaron muchas emociones de la lectura, pues los testimonios que trabaja la Comisión de la Verdad son muy fuertes…”.
Luisa

Investigadores de la Universidad EAFIT indagaron sobre las posibilidades y reparos que tiene las empresas privadas en invertir en el sector de la justicia, y así mejorar estas condiciones que hoy son precarias.
Pompilio Peña, colaboradorSon múltiples las dificultades que sufre el ciudadano de a pie al momento de acceder a la justicia. Muchos de los sistemas locales de justicia, que constituyen una sinergia que concentra la oferta de la defensa de derechos, no cuentan con funcionarios suficientes, carecen de infraestructura adecuada, falta mobiliario apropiado, trabajan con computadoras desactualizadas, adolecen de buen acceso a Internet y hasta de tinta para imprimir acuerdos conciliatorios.
Esa crítica situación fue abordada por investigadores de la Universidad EAFIT a través de la consultoría titulada ¿Debe invertir el sector privado en el acceso a la justicia?, financiada con recursos de la Agencia de los Estados Unidos para el Desarrollo Internacional (USAID) y liderada por Alejandro Gómez Velázquez, profesor titular de la Escuela de Derecho.
PorDel contexto de insatisfacción al acceso a la justicia surgieron dos preguntas rectoras: ¿existe el deber del sector privado de intervenir en las posibilidades de acceso a la justicia en Colombia? ¿Qué rol juega el sector privado en esta contingencia?
“Para responder estos interrogantes, la consultoría tuvo dos momentos. El primero fue un acercamiento teórico a la problemática; y el segundo, como ejercicio práctico, lo constituyó una serie de entrevistas semiestructuradas a empresas privadas. A ellas se les consultó si hacían o no inversiones para apoyar al ciudadano para acceder a la justicia, cuáles eran las razones para hacerlo y cuáles eran sus reparos”, explicó Gómez.
La investigación –agregó el docente– arrojó tres hallazgos principales y se identificaron cuatro mitos que frenaron a los empresarios para dar el salto a la inversión.
El primer hallazgo fue que, al menos teóricamente, desde una percepción amplia del acceso a la justicia, existen fundamentos como el de grupos de interés (stakeholders) que hacen deseable, e incluso provechoso, para el sector privado invertir en este campo. Esto quiere decir que no solo por razones filantrópicas sino también estratégicas, el sector privado tiene buenas razones para incrementar su aporte en el sector.
“El segundo hallazgo fue sorpresivo. Nos preguntamos si las empresas venían o no ya interviniendo en temas de justicia. Esto tiene que ver con el marco práctico que desarrollamos donde hicimos entrevistas. Este hallazgo fue sorpresivo porque si bien las empresas en un principio fueron bastante renuentes a darnos información, algunas de ellas sí lo hicieron y pudimos constatar que ya venían invirtiendo en justicia desde una concepción amplia”, precisó el docente.
El tercer hallazgo desveló las razones que tienen las empresas para intervenir o no. La investigación comprobó que ellas lo hacen por razones altruistas, pero también por razones estratégicas. Lo que indica que algunas empresas ven necesario intervenir en temas de acceso a la justicia incluso con el propósito de mejorar procesos internos que tienen que ver con sus actividades productivas.
En esta fase fueron consultadas 13 empresas (de los sectores minero-energético, agroindustrial, alimentos y bebidas, energía, financiero, construcción, manufacturas y servicios públicos), ocho fundaciones empresariales, dos universidades privadas, tres cámaras de comercio y tres expertos.
Encontramos, a manera de ejemplo, que hay entidades que pagan la formación de jóvenes mediadores de conflictos”.
AlejandroGómez Velázquez, profesor titular de la Escuela de Derecho. * Las visitas en terreno fueron en las Casas de Justicia de Apartadó y Chigorodó, en el Urabá antioqueño, y en las ubicadas en los barrios Alfonso López, Siloé y Agua Blanca, en la ciudad de Cali.
Una de las preocupaciones de un grupo de investigadores es cómo acercar la justicia al ciudadano. Algunos creen que en ese proceso debe intervenir la empresa privada.
De estos hallazgos se desprendieron cuatro grandes mitos que funcionan como reparos que limitan a las empresas a la hora de invertir más ampliamente en el sector de la justicia.
El primer mito se refiere a que las empresas no sabían medir el impacto de su inversión. “Ahí lo que hicimos fue una revisión juiciosa de la bibliografía comparada, y encontramos que ya en otros países se viene midiendo tal rédito. A partir de allí realizamos una aproximación de dichos cálculos al ámbito colombiano. La relación encontrada fue bastante alentadora: nos mostró que un peso invertido podría generar casi nueve pesos de rendimiento social de esa inversión”, indicó el docente.
El segundo mito apunta a los riesgos reputacionales. Las empresas temen invertir en justicia por lo que se pueda desprender de tal acción, afectando su imagen. Sin embargo, el grupo de investigación concluyó que este mito podría disminuirse y controlarse si las inversiones se dieran en las primeras dimensiones del acceso a la justicia, que tienen que ver con propiciar un ambiente favorable, con el acceso a la información, a la tecnología y otros servicios. Las empresas, incluso, podrían contribuir y mejorar infraestructuras y hacer donaciones en especie.
El tercer mito está relacionado con que las empresas entienden que invertir en justicia puede causar una injerencia indebida en la autonomía judicial. Al respecto, Gómez aclaró que “si bien somos conscientes de esos riesgos, también creemos que hay estrategias para disminuirlos. Hay intervenciones muy puntuales que pueden darse en infraestructura o donaciones, y que no afectarían la independencia de los funcionarios judiciales".
El cuarto mito hizo referencia a la asunción de funciones estatales por el sector privado. Explicó el docente que “algunas empresas nos dijeron que la función de administrar justicia es propia del Estado y que ellas no deberían intervenir en ello. Si bien reconocemos que es así, creemos que las empresas pueden y deben sumarse a los esfuerzos que ya en este campo realiza el Estado para incrementar el impacto y hacer sostenibles en el tiempo dichas inversiones. No se trata que los privados paguen los salarios de los jueces, los comisarios de familia o los defensores de familia, pero sí que pueden aportar para garantizar el acceso a los servicios que ellos presten en todo el territorio nacional”.
 Alejandro Luis Acevedo, director del programa de Justicia Inclusiva de USAID.
Alejandro Luis Acevedo, director del programa de Justicia Inclusiva de USAID.
Hay intervenciones muy puntuales que pueden darse en infraestructura o donaciones, y que no afectarían la independencia de los funcionarios judiciales”.
Alejandro Gómez Velázquez, profesor titular de la Escuela de Derecho.
Algunas otras recomendaciones para disipar los mitos sobre la inversión del sector privado en el acceso a la justicia
Propiciar la transferencia de conocimiento entre las organizaciones y las instituciones del sistema de justicia.
1 3 2 4
Considerar la destinación de recursos en especie -tales como papelería, implementos de oficina, material publicitario y equipos-, de infraestructura o de conectividad para ampliar la capacidad de atención de núcleos institucionales como las Casas de Justicia.
La respuesta es sí. Se hallaron diversas empresas que invierten en generar un ambiente favorable para evitar disputas entre ciudadanos. “Y ahí encontramos, a manera de ejemplo, que hay entidades que pagan la formación de jóvenes mediadores de conflictos”, afirmó el docente. Las empresas también invierten en empoderamiento legal, que consiste en instruir a las personas en el reconocimiento de sus derechos y cuándo son vulnerados. De igual forma, se encontró inversión en la asistencia legal, consistente en el pago de asesorías para la titulación de tierras. Fueron igualmente reconocidas inversiones en materia de acceso a las instituciones para la resolución de conflictos.
A la par, se encontraron casos de fundaciones empresariales que pagaron la implementación de sistemas de gestión y control de calidad a jueces civiles a fin de mejorar su eficiencia. Frente a esto, el docente dijo que “nos llamó la atención esto porque son intervenciones directas en la rama judicial, pero que creemos no por ello afectan la autonomía y la independencia de los jueces, sino que por el contrario ayudan a mejorar su desempeño”.
Promover la celebración de convenios de impulso o de asociación entre entidades privadas sin ánimo de lucro que aglutinen inversiones en justicia y las distintas entidades estatales.
Implemetar estrategias de redireccionamiento a las instituciones como parte de las actividades de la organización.
Finalmente, el acercamiento a este tema por medio de la consultoría arrojó que es “esperanzador” el rendimiento social y de inversión que el sector privado puede llegar a hacer en la justicia y que este debe precisarse con estudios posteriores en la materia.
En palabras del profesor Gómez, “el principal mérito de esta consultoría es atrevernos a romper paradigmas y abrir una conversación que parece ser esperanzadora en torno al vínculo que puede tejerse entre el sector privado y el derecho de acceso a la justicia en condiciones más accesibles, inclusivas y oportunas para todos los colombianos”
Esta investigación hace parte del programa de Justicia Inclusiva que ejecuta Chemonics, con recursos de USAID. El equipo de la consultoría fue conformado también por las abogadas Carolina Rojas y Mariana Toro, con el apoyo de la docente de la Escuela de Administración, María Alejandra González Pérez, y de Henry Puerta, profesor de cátedra de la Escuela de Economía, Finanzas y Gobierno.
¿Las empresas invierten hoy en el acceso a la justicia?
¿Conoces las flores que hay cerca de tu casa o en tu barrio?, ¿a qué huelen?, ¿qué animales has visto visitando las flores? Utiliza esta guía de observación de flores y polinizadores, elaborada en el proyecto “Ciencia entre montañas”, y explora tu entorno para descubrir todo lo que la naturaleza nos enseña.
Por Daniela Cepeda Zúñiga, Susana Galvis Bravo y Agustín Patiño Orozco, colaboradoresIlustraciones: Carolina Arango Hurtado

¿A los osos les gusta la miel?, ¿por qué los aguacates tienen semilla?, ¿cómo la niebla se convierte en el agua que tomamos?, ¿cómo son las flores que hay cerca de tu casa? Estas son preguntas de los niños y niñas participantes del proyecto “Ciencia entre montañas”, liderado por la Universidad de los niños EAFIT en los municipios de la Provincia Cartama, de la subregión del Suroeste antioqueño.
A través del juego, la pregunta, la experimentación y la conversación, más de 1100 niños y niñas participantes viven experiencias de aprendizaje activo que los acercan a la ciencia y la investigación. Los acompañan mediadores locales, capacitados por el área de Apropiación Social del Conocimiento de EAFIT y asesorados por investigadores invitados.
Entre 2022 y 2025, Ciencia entre montañas realizará un total de 960 talleres en 40 sedes educativas rurales de los municipios de Caramanta, Fredonia, Jericó, Montebello, Pueblorrico, Santa Bárbara, Támesis, Tarso, Valparaíso y Venecia.
Una de las experiencias de aprendizaje desarrolladas en las sedes educativas participantes buscó responder la pregunta ¿De dónde sacan las flores su aroma? en compañía del investigador Luis Fernando Echeverri, químico farmacéutico y doctor en Ciencias Químicas.
Los niños y niñas participantes del proyecto “Ciencia entre montañas” intercambian cartas con los investigadores para compartir sus experiencias de aprendizaje.
El proyecto Ciencia entre montañas es liderado por la Universidad EAFIT con la experiencia metodológica de la Universidad de los niños en alianza con Comfama y la Fundación Fomento a la Educación Julio C. Hernández, y financiado con recursos del Sistema General de Regalías, con la supervisión de Minciencias.
Hola Luis, hoy aprendimos sobre la polinización de las flores, jugamos e hicimos un experimento, y aprendimos que las flores sueltan su aroma desde sus células vegetales y los insectos vienen a polinizar. Las flores cuando se sienten atacadas sueltan un aroma que huele mal. Nos gustó tu carta ¡y muchos abrazos!”.

Darcy Cañaveral Ciro y Yakeline Álvarez Tangarife, I. E. Sabanitas Sede Educativa Rural Sabanitas, Municipio de Montebello.
Durante este taller, los niños y niñas estudiaron la anatomía básica de las flores, realizaron recorridos por su vecindario para identificar distintos tipos de flores y animales polinizadores, diseccionaron flores observando su estructura interna con una lupa, y experimentaron con la extracción de aceites esenciales de canela, clavos de olor y eucalipto macerándolos en alcohol durante un par de semanas.
Guía de observación de flores y polinizadores 1
Los polinizadores que visitan nuestras flores
Realiza un recorrido por las zonas verdes que están cerca de tu casa o en tu barrio y observa las flores que hay en el suelo, en los árboles o creciendo en las grietas de los andenes. Lleva papel y lápiz y registra todos tus hallazgos en el siguiente formato:
Elige una flor, obsérvala, tómale fotos, huélela y escribe tus hallazgos:
¿Cómo es la flor? Describe el color, tamaño y forma de la flor:
¿Tiene polen? ¿Cómo es?
¿Tiene olor? ¿A qué huele?
¿La flor tiene visitantes? Describe los animales que observaste visitando la flor:
Identifica el sexo de la flor


Observa muy bien cada una de las partes de la flor y trata de identificar:
¿Es hermafrodita?





La mayoría de las plantas angiospermas (plantas con flores) son hermafroditas, es decir, tienen flores con partes masculinas y femeninas, como el curubo antioqueño (Passiflora antioquiensis) o el aguacate (Persea americana).








¿Es femenina?
Estas flores tienen solo la parte femenina que se encuentran en las hermafroditas. En ellas se puede identificar el estigma, que es la parte del pistilo que recibe el polen. También el estilo alargado en cuyo interior se encuentran los óvulos.
¿Es masculina?
Estas flores tienen solo la parte masculina. En ellas se pueden las anteras, que por lo regular tienen polen.
El estigma es la parte del pistilo que recibe el polen. En lo profundo del estilo están los óvulos de las flores.
Las anteras son la parte del estambre que produce el polen. El polen es transportado por los polinizadores desde los estambres hasta los estigmas de una flor hermafrodia o femenina.

Se trata del Talaromyces santanderensis, hallado recientemente en suelos contaminados con cadmio en una finca cacaotera de la vereda Monserrate del municipio de San Vicente de Chucurí, en Norte de Santander. En laboratorios de la Universidad EAFIT se avanza en la caracterización microbiológica.

Producir cacao de alta calidad depende, entre otras cosas, de bajar los niveles de contaminación por metales pesados que se almacenan en la semilla. La buena noticia es que un hongo descubierto recientemente por investigadoras e investigadores de las universidades EAFIT y Santander es ahora clave para retener el metal pesado en el suelo y prevenir que se almacene en los frutos.
Esta nueva especie está bajo análisis en el Laboratorio de Biología Molecular de EAFIT, donde se espera descifrar su código genético, así como entender por qué es altamente tolerante al cadmio, uno de los metales pesados más presentes en suelos cacaoteros, y con base en los hallazgos idear soluciones biotecnológicas que permitan mejoraría su calidad para el consumo humano, además y de abrir nuevas puertas para la comercialización en los mercados internacionales.
En imágenes, mostramos detalles de los procesos de análisis en sus distintas fases.
Fotografías: Robinson Henao Micelio en crecimiento del hongo T. santanderensis.

Observación de caracteres micromorfológicos
El investigador Javier C. Álvarez replica la cepa fúngica en una cámara de flujo laminar estéril para evitar contaminación.

Observación detallada del micelio.
PCR para la amplificación de marcadores moleculares claves en la identificación genética de la cepa.


La investigadora
Manuela Quiroga nos enseña cómo se lleva a cabo la extracción del material genético.

Preparación del micelio del hongo para ser transferido y replicado.
Observación de fragmentos de ADN amplificados en una PCR.


Observación detallada del micelio.
Talaromyces santanderensis muestra múltiples cambios morfológicos y respuesta biológica de supervivencia a medios con alta concentración de cadmio.

Técnica de perforación en el micelio de la cepa original para dar lugar a nuevas generaciones en diversos medios de cultivo para la evaluación de cambios morfológicos.
Proceso de extracción de ADN del hongo para la identificación genética usando PCR, electroforesis y secuenciación.



Gel de electroforesis en agarosa posterior a la extracción de DNA y PCR para evaluar la calidad y tamaño del material genético.
Genes específicos (ITS, BenA, CaM y RPB2) son amplificados en un termociclador para la identificación filogenética de la nueva especie de hongo.




¡Uno de los congresos de economía más grandes del mundo!